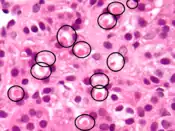

| |
 | |
| Clinical data | |
|---|---|
| Pronunciation | /ˌspaɪroʊnoʊˈlæktoʊn/ SPY-roh-noh-LAK-tone,[1] /ˌspɪəroʊnoʊˈlæktoʊn/ SPEER-oh-noh-LAK-tone[2] |
| Trade names | Aldactone, others |
| Other names | SC-9420; NSC-150339; 7α-Acetylthiospirolactone; 7α-Acetylthio-17α-hydroxy-3-oxopregn-4-ene-21-carboxylic acid γ-lactone |
| AHFS/Drugs.com | Monograph |
| MedlinePlus | a682627 |
| License data | |
| Pregnancy category |
|
| Routes of administration | By mouth,[4] topical[5] |
| Drug class | Antimineralocorticoid; Steroidal antiandrogen |
| ATC code | |
| Legal status | |
| Legal status | |
| Pharmacokinetic data | |
| Bioavailability | 60–90%[11][12][13] |
| Protein binding | Spironolactone: 88% (to albumin and AGP)[14] Canrenone: 99.2% (to albumin)[14] |
| Metabolism | Liver, others: • Deacetylation via CES • S-Oxygenation via FOM • S-Methylation via TMT • Dethioacetylation • Hydroxylation via CYP3A4 • Lactone hydrolysis via PON3[11][12][15][16][17][18][19] |
| Metabolites | 7α-TS, 7α-TMS, 6β-OH-7α-TMS, canrenone, others[11][12][20] (All three active)[21] |
| Elimination half-life | Spironolactone: 1.4 hrs[11] 7α-TMS: 13.8 hours[11] 6β-OH-7α-TMS: 15.0 hrs[11] Canrenone: 16.5 hours[11] |
| Excretion | Urine, bile[12] |
| Identifiers | |
| |
| CAS Number | |
| PubChem CID | |
| IUPHAR/BPS | |
| DrugBank | |
| ChemSpider | |
| UNII | |
| KEGG | |
| ChEBI | |
| ChEMBL | |
| CompTox Dashboard (EPA) | |
| ECHA InfoCard | 100.000.122 |
| Chemical and physical data | |
| Formula | C24H32O4S |
| Molar mass | 416.58 g·mol−1 |
| 3D model (JSmol) | |
| Melting point | 134 to 135 °C (273 to 275 °F) |
| |
| |
| (verify) | |

Spironolactone, sold under the brand name Aldactone among others, is a medication that is primarily used to treat fluid build-up due to heart failure, liver scarring, or kidney disease.[4] It is also used in the treatment of high blood pressure, low blood potassium that does not improve with supplementation, early puberty in boys, acne and excessive hair growth in women, and as a part of feminizing hormone therapy in trans women.[4][22][23] Spironolactone is taken by mouth.[4]
Common side effects include electrolyte abnormalities, particularly high blood potassium, nausea, vomiting, headache, rashes, and a decreased desire for sex.[4] In those with liver or kidney problems, extra care should be taken.[4] Spironolactone has not been well studied in pregnancy and should not be used to treat high blood pressure of pregnancy.[3] It is a steroid that blocks the effects of the hormones aldosterone and testosterone and has some estrogen-like effects.[4][24] Spironolactone belongs to a class of medications known as potassium-sparing diuretics.[4]
Spironolactone was discovered in 1957, and was introduced in 1959.[25][26][27] It is on the World Health Organization's List of Essential Medicines.[28][29] It is available as a generic medication.[4] In 2020, it was the 51st most commonly prescribed medication in the United States, with more than 13 million prescriptions.[30][31]
Medical uses
Spironolactone is used primarily to treat heart failure, edematous conditions such as nephrotic syndrome or ascites in people with liver disease, essential hypertension, low blood levels of potassium, secondary hyperaldosteronism (such as occurs with liver cirrhosis), and Conn's syndrome (primary hyperaldosteronism). The most common use of spironolactone is in the treatment of heart failure.[32] On its own, spironolactone is only a weak diuretic because it primarily targets the distal nephron (collecting tubule), where only small amounts of sodium are reabsorbed, but it can be combined with other diuretics to increase efficacy. The classification of spironolactone as a "potassium-sparing diuretic" has been described as obsolete.[33] Spironolactone is also used to treat Bartter's syndrome due to its ability to raise potassium levels.[34]
Spironolactone has antiandrogenic activity. For this reason, it is frequently used to treat a variety of dermatological conditions in which androgens play a role. Some of these uses include acne, seborrhea, hirsutism, and pattern hair loss in women.[35] Spironolactone is the most commonly used medication in the treatment of hirsutism in the United States.[36] High doses of spironolactone, which are needed for considerable antiandrogenic effects, are not recommended for men due to the high risk of feminization and other side effects. Spironolactone can be used to treat symptoms of hyperandrogenism, such as due to polycystic ovary syndrome.[37]
Heart failure
While loop diuretics remain first-line for most people with heart failure, spironolactone has shown to reduce both morbidity and mortality in numerous studies and remains an important agent for treating fluid retention, edema, and symptoms of heart failure. Current recommendations from the American Heart Association are to use spironolactone in patients with NYHA Class II-IV heart failure who have a left ventricular ejection fraction of less than 35%.[38]
Spironolactone improves left ventricular diastolic function in patients with heart failure with preserved ejection fraction, however it has no effect on mortality and hospitalization.[39][40]
Due to its antiandrogenic properties, spironolactone can cause effects associated with low androgen levels and hypogonadism in males. For this reason, men are typically not prescribed spironolactone for any longer than a short period of time, e.g., for an acute exacerbation of heart failure. A newer medication, eplerenone, has been approved by the U.S. Food and Drug Administration for the treatment of heart failure, and lacks the antiandrogenic effects of spironolactone. As such, it is far more suitable for men for whom long-term medication is being chosen. However, eplerenone may not be as effective as spironolactone or the related medication canrenone in reducing mortality from heart failure.[41]
The clinical benefits of spironolactone as a diuretic are typically not seen until 2–3 days after dosing begins. Likewise, the maximal antihypertensive effect may not be seen for 2–3 weeks.
Unlike with some other diuretics, potassium supplementation should not be administered while taking spironolactone, as this may cause dangerous elevations in serum potassium levels resulting in hyperkalemia and potentially deadly abnormal heart rhythms.
High blood pressure
About 1 in 100 people with hypertension have elevated levels of aldosterone; in these people, the antihypertensive effect of spironolactone may exceed that of complex combined regimens of other antihypertensives since it targets the primary cause of the elevated blood pressure. However, a Cochrane review found adverse effects at high doses and little effect on blood pressure at low doses in the majority of people with high blood pressure.[42] There is no evidence of person-oriented outcome at any dose in this group.[42]
High aldosterone levels
Spironolactone is used in the treatment of hyperaldosteronism (high aldosterone levels or mineralocorticoid excess), for instance primary aldosteronism (Conn's syndrome).[43] Antimineralocorticoids like spironolactone and eplerenone are first-line treatments for hyperaldosteronism.[43] They improve blood pressure and potassium levels, as well as left ventricular hypertrophy, albuminuria, and carotid intima-media thickness, in people with primary aldosteronism.[43] In people with hyperaldosteronism due to unilateral aldosterone-producing adrenocortical adenoma, adrenalectomy should be preferred instead of antimineralocorticoids.[43] Spironolactone should not be used to treat primary aldosteronism in pregnancy due to its antiandrogen-related risk of teratogenicity in male fetuses.[44][45][46][47]
Skin and hair conditions
Androgens like testosterone and DHT play a critical role in the pathogenesis of a number of dermatological conditions including oily skin, acne, seborrhea, hirsutism (excessive facial/body hair growth in women), and male pattern hair loss (androgenic alopecia).[48][49] In demonstration of this, women with complete androgen insensitivity syndrome (CAIS) do not produce sebum or develop acne and have little to no body, pubic, or axillary hair.[50][51] Moreover, men with congenital 5α-reductase type II deficiency, 5α-reductase being an enzyme that greatly potentiates the androgenic effects of testosterone in the skin, have little to no acne, scanty facial hair, reduced body hair, and reportedly no incidence of male-pattern hair loss.[52][53][54][55][56] Conversely, hyperandrogenism in women, for instance due to polycystic ovary syndrome (PCOS) or congenital adrenal hyperplasia (CAH), is commonly associated with acne and hirsutism as well as virilization (masculinization) in general.[48] In accordance with the preceding, antiandrogens are highly effective in the treatment of the aforementioned androgen-dependent skin and hair conditions.[57][58]
Because of the antiandrogenic activity of spironolactone, it can be quite effective in treating acne in women.[59][60][61] In addition, spironolactone reduces oil that is naturally produced in the skin and can be used to treat oily skin.[60][62][49] Though not the primary intended purpose of the medication, the ability of spironolactone to be helpful with problematic skin and acne conditions was discovered to be one of the beneficial side effects and has been quite successful.[60][62] Oftentimes, for women treating acne, spironolactone is prescribed and paired with a birth control pill.[60][62] Positive results in the pairing of these two medications have been observed, although these results may not be seen for up to three months.[60][62] Spironolactone has been reported to produce a 50 to 100% improvement in acne at sufficiently high doses.[63] Response to treatment generally requires 1 to 3 months in the case of acne and up to 6 months in the case of hirsutism.[63] Ongoing therapy is generally required to avoid relapse of symptoms.[63] Spironolactone is commonly used in the treatment of hirsutism in women, and is considered to be a first-line antiandrogen for this indication.[64] Spironolactone can be used in the treatment of female-pattern hair loss (pattern scalp hair loss in women).[65] There is tentative low quality evidence supporting its use for this indication.[66] Although apparently effective, not all cases of female-pattern hair loss are dependent on androgens.[67]
Antiandrogens like spironolactone are male-specific teratogens which can feminize male fetuses due to their antiandrogenic effects.[57][68][69] For this reason, it is recommended that antiandrogens only be used to treat women who are of reproductive age in conjunction with adequate contraception.[57][68][69] Oral contraceptives, which contain an estrogen and a progestin, are typically used for this purpose.[57] Moreover, oral contraceptives themselves are functional antiandrogens and are independently effective in the treatment of androgen-dependent skin and hair conditions, and hence can significantly augment the effectiveness of antiandrogens in the treatment of such conditions.[57][70]
Spironolactone is not generally used in men for the treatment of androgen-dependent dermatological conditions because of its feminizing side effects, but it is effective for such indications in men similarly.[65] As an example, spironolactone has been reported to reduce symptoms of acne in males.[71] An additional example is the usefulness of spironolactone as an antiandrogen in transgender women.[72][73][74]
Topical spironolactone has been found to be effective in the treatment of acne as well.[75] As a result, topical pharmaceutical formulations containing 2% or 5% spironolactone cream became available in Italy for the treatment of acne and hirsutism in the early 1990s.[76][77] The products were discontinued in 2006 when the creams were added to the list of doping substances with a decree of the Ministry of Health that year.[77]
Comparison
Spironolactone, the 5α-reductase inhibitor finasteride, and the nonsteroidal antiandrogen flutamide all appear to have similar effectiveness in the treatment of hirsutism.[64][78][79] However, some clinical research has found that the effectiveness of spironolactone for hirsutism is greater than that of finasteride but is less than that of flutamide.[64] The combination of spironolactone with finasteride is more effective than either alone for hirsutism and the combination of spironolactone with a birth control pill is more effective than a birth control pill alone.[64] One study showed that spironolactone or the steroidal antiandrogen cyproterone acetate both in combination with a birth control pill had equivalent effectiveness for hirsutism.[64] Spironolactone is considered to be a first-line treatment for hirsutism, finasteride and the steroidal antiandrogen cyproterone acetate are considered to be second-line treatments, and flutamide is no longer recommended for hirsutism due to liver toxicity concerns.[64] The nonsteroidal antiandrogen bicalutamide is an alternative option to flutamide with improved safety.[80][81]
The combination of spironolactone with a birth control pill in the treatment of acne appears to have similar effectiveness to a birth control pill alone and the combination of a birth control pill with cyproterone acetate, flutamide, or finasteride.[60] However, this was based on low- to very-low-quality evidence.[60] Spironolactone may be more effective than birth control pills in the treatment of acne, and the combination of spironolactone with a birth control pill may have greater effectiveness for acne than either alone.[82] In addition, some clinical research has found that flutamide is more effective than spironolactone in the treatment of acne.[60] In one study, flutamide decreased acne scores by 80% within 3 months, whereas spironolactone decreased symptoms by only 40% in the same time period.[83][84][85] However, the use of flutamide for acne is limited by its liver toxicity.[86][87][88][89] Bicalutamide is a potential alternative to flutamide for acne as well.[90][91] Spironolactone can be considered as a first-line treatment for acne in those who have failed other standard treatments such as topical therapies and under certain other circumstances, although this is controversial due to the side effects of spironolactone and its teratogenicity.[82][58]
There is insufficient clinical evidence to compare the effectiveness of spironolactone with other antiandrogens for female-pattern hair loss.[92] The effectiveness of spironolactone in the treatment of both acne and hirsutism appears to be dose-dependent, with higher doses being more effective than lower doses.[82][93][94] However, higher doses also have greater side effects, such as menstrual irregularities.[60]
Transgender hormone therapy
Spironolactone is frequently used off-label as a component of feminizing hormone therapy in transgender women, especially in the United States (where cyproterone acetate is not available), usually in addition to an estrogen.[72][73][74] Effects in transgender women may include decreased male pattern body hair, induction of breast development and of feminization in general, and reduced spontaneous erections.[74]
Forms
Spironolactone is available in the form of tablets (25 mg, 50 mg, 100 mg; brand name Aldactone, others) and suspensions (25 mg/5 mL; brand name CaroSpir) for use by mouth.[95][96][97][98][99] It has also been marketed in the form of 2% and 5% topical cream in Italy for the treatment of acne and hirsutism under the brand name Spiroderm, but this product is no longer available.[5][100] The medication is also available in combination with other medications, such as hydrochlorothiazide (brand name Aldactazide, others).[99][101] Spironolactone has poor water solubility, and for this reason, only oral and topical formulations have been developed; other routes of administration such as intravenous injection are not used.[11] The only antimineralocorticoid that is available as a solution for parenteral use is the related medication potassium canrenoate.[102]
Contraindications
Contraindications of spironolactone include hyperkalemia (high potassium levels), severe and end-stage kidney disease (due to high hyperkalemia risk, except possibly in those on dialysis), Addison's disease (adrenal insufficiency and low aldosterone levels), and concomitant use of eplerenone.[8][103] It should also be used with caution in people with certain neurological disorders, as well as those who experience or have experienced anuria (lack of urine production), acute kidney injury, or significant impairment of kidney excretory function with risk of hyperkalemia.[8]
Side effects
One of the most common side effects of spironolactone is frequent urination. Other general side effects include dehydration, hyponatremia (low sodium levels), mild hypotension (low blood pressure),[83] ataxia (muscle incoordination), drowsiness, dizziness,[83] dry skin, and rashes. Because of its antiandrogenic activity, spironolactone can, in men, cause breast tenderness, gynecomastia (breast development), feminization in general, and demasculinization, as well as sexual dysfunction including loss of libido and erectile dysfunction, although these side effects are usually confined to high doses of spironolactone.[104] At very high doses (400 mg/day), spironolactone has also been associated with testicular atrophy and reversibly reduced fertility, including semen abnormalities such as decreased sperm count and motility in men.[105][106] However, such doses of spironolactone are rarely used clinically.[106] In women, spironolactone can cause menstrual irregularities, breast tenderness, and breast enlargement.[35][60][107] Aside from these adverse effects, the side effects of spironolactone in women taking high doses are minimal, and it is well tolerated.[60][83][108]
The most important potential side effect of spironolactone is hyperkalemia (high potassium levels), which, in severe cases, can be life-threatening.[8] Hyperkalemia in these people can present as a normal anion-gap metabolic acidosis.[8] It has been reported that the addition of spironolactone to loop diuretics in patients with heart failure was associated with a higher risk of hyperkalemia and acute kidney injury (AKI).[109] Spironolactone may put people at a heightened risk for gastrointestinal issues like nausea, vomiting, diarrhea, cramping, and gastritis.[8][110] In addition, there has been some evidence suggesting an association between use of the medication and bleeding from the stomach and duodenum,[8] though a causal relationship between the two has not been established.[111][112] Also, spironolactone is immunosuppressive in the treatment of sarcoidosis.[113]
Most of the side effects of spironolactone are dose-dependent.[59] Low-dose spironolactone is generally very well tolerated.[59] Even higher doses of spironolactone, such as 100 mg/day, are well tolerated in most individuals.[59] Dose-dependent side effects of spironolactone include menstrual irregularities, breast tenderness and enlargement, orthostatic hypotension, and hyperkalemia.[59] The side effects of spironolactone are usually mild and rarely result in discontinuation.[59]
| Side effect | RCTs (n (ITT) = 326) | Case series (n (ITT) = 663) | ||
|---|---|---|---|---|
| Number | % | Number | % | |
| Menstrual irregularities | 38 | 13.4 (of 283) | 216 | 33.4 (of 646) |
| Breast tenderness | 8 | 2.5 | 30 | 4.5 |
| Breast enlargement | 7 | 2.1 | 13 | 2.0 |
| Dizziness/vertigo/lightheadedness | 11 | 3.4 | ≥19a | ≥2.9 |
| Headache | 5 | 1.5 | ≥10a | ≥1.5 |
| Nausea and/or vomiting | 6 | 1.8 | 24 | 3.6 |
| Weight gainb | 5 | 1.5 | 1 | 0.2 |
| Abdominal pain | 0 | 0 | ≥11a | ≥1.7 |
| Polyuria | 2 | 0.6 | 8 | 1.2 |
| Fatigue/lethargy | 1 | 0.3 | ≥12a | ≥1.8 |
| Footnotes: a = Precise values unavailable due to inadequate reporting. b = Not monitored in most studies. Description: Side effects of spironolactone (25–400 mg/day) with ≥1% incidence in a 2017 hybrid systematic review of clinical studies of spironolactone for acne in women. Side effects with <1% incidence included postural hypotension, depression, diarrhea, muscle pain, increased appetite, drowsiness, rashes/drug eruptions, chloasma-like skin pigmentation, polydipsia, weakness, leg edema, libido changes, and palpitations. [...] Certain side effects, like breast enlargement, reduced premenstrual symptoms, and less oily skin/greasy hair, could be beneficial. Side effects often could not be unambiguously attributed to spironolactone due concomitant use of other medications, particularly birth control pills. Hyperkalemia was rare (14/469; 3.0%) and was "invariably mild and clinically insignificant". Risk of bias was high and quality of evidence was low to very low. Sources: See template. | ||||
High potassium levels
Spironolactone can cause hyperkalemia, or high blood potassium levels.[106] Rarely, this can be fatal.[106] Of people with heart disease prescribed typical dosages of spironolactone, 10 to 15% develop some degree of hyperkalemia, and 6% develop severe hyperkalemia.[106] At a higher dosage, a rate of hyperkalemia of 24% has been observed.[114] An abrupt and major increase in the rate of hospitalization due to hyperkalemia from 0.2% to 11% and in the rate of death due to hyperkalemia from 0.3 per 1,000 to 2.0 per 1,000 between early 1994 and late 2001 has been attributed to a parallel rise in the number of prescriptions written for spironolactone upon the publication of the Randomized Aldactone Evaluation Study (RALES) in July 1999.[106][114][115][32] However, another population-based study in Scotland failed to replicate these findings.[116][117] The risk of hyperkalemia with spironolactone is greatest in the elderly, in people with renal impairment (e.g., due to chronic kidney disease or diabetic nephropathy), in people taking certain other medications (including ACE inhibitors, angiotensin II receptor blockers, nonsteroidal anti-inflammatory drugs, the antibiotic trimethoprim, and potassium supplements), and at higher dosages of spironolactone.[106][32][118][119]
Although spironolactone poses an important risk of hyperkalemia in the elderly, in those with kidney or cardiovascular disease, and/or in those taking medications or supplements which increase circulating potassium levels, a large retrospective study found that the rate of hyperkalemia in young women without such characteristics who had been treated with high doses of spironolactone for dermatological conditions did not differ from that of controls.[60][62][120] This was the conclusion of a 2017 hybrid systematic review of studies of spironolactone for acne in women as well, which found that hyperkalemia was rare and was invariably mild and clinically insignificant.[60] These findings suggest that hyperkalemia may not be a significant risk in such individuals, and that routine monitoring of circulating potassium levels may be unnecessary in this population.[60][62][120] However, other sources have claimed that hyperkalemia can nonetheless also occur in people with more normal renal function and presumably without such risk factors.[32] Occasional testing on a case-by-case basis in those with known risk factors may be justified.[60] Side effects of spironolactone which may be indicative of hyperkalemia and if persistent could justify serum potassium testing include nausea, fatigue, and particularly muscle weakness.[60] Notably, non-use of routine potassium monitoring with spironolactone in young women would reduce costs associated with its use.[60]
Breast changes
Spironolactone frequently causes breast pain and breast enlargement in women.[121][122] This is "probably because of estrogenic effects on target tissue."[106] At low doses, breast tenderness has been reported in only 5% of women, but at high doses, it has been reported in up to 40% of women.[123][59] Breast enlargement and tenderness may occur in 26% of women at high doses.[83] Some women regard spironolactone-induced breast enlargement as a positive effect.[60]
Spironolactone also commonly and dose-dependently produces gynecomastia (breast development) as a side effect in men.[105][122][124][125] At low doses, the rate is only 5 to 10%,[125] but at high doses, up to or exceeding 50% of men may develop gynecomastia.[105][122][124] In the RALES, 9.1% of men taking 25 mg/day spironolactone developed gynecomastia, compared to 1.3% of controls.[126] Conversely, in studies of healthy men given high-dose spironolactone, gynecomastia occurred in 3 of 10 (30%) at 100 mg/day, in 5 of 8 (62.5%) at 200 mg/day, and in 6 of 9 (66.7%) at 400 mg/day, relative to none of 12 controls.[127][128] The severity of gynecomastia with spironolactone varies considerably, but is usually mild.[105] As with breast enlargement caused by spironolactone in women, gynecomastia due to spironolactone in men is often although inconsistently accompanied by breast tenderness.[105] In the RALES, only 1.7% of men developed breast pain, relative to 0.1% of controls.[126]
The time to onset of spironolactone-induced gynecomastia has been found to be 27 ± 20 months at low doses and 9 ± 12 months at high doses.[126] Gynecomastia induced by spironolactone usually regresses after a few weeks following discontinuation of the medication.[105] However, after a sufficient duration of gynecomastia being present (e.g., one year), hyalinization and fibrosis of the tissue occurs and drug-induced gynecomastia may become irreversible.[129][130]
Menstrual disturbances
Spironolactone at higher doses can cause menstrual irregularities as a side effect in women.[59] These irregularities include metrorrhagia (intermenstrual bleeding), amenorrhea (absence of menstruation), and breakthrough bleeding.[59] They are common during spironolactone therapy, with 10 to 50% of women experiencing them at moderate doses and almost all experiencing them at a high doses.[83][106] For example, about 20% of women experienced menstrual irregularities with 50 to 100 mg/day spironolactone, whereas about 70% experienced menstrual irregularities at 200 mg/day.[59] Most women taking moderate doses of spironolactone develop amenorrhea, and normal menstruation usually returns within two months of discontinuation.[106] Spironolactone produces an irregular and anovulatory pattern of menstrual cycles.[83] It is also associated with metrorrhagia and menorrhagia (heavy menstrual bleeding) in large percentages of women,[121] as well as with polymenorrhea (short menstrual cycles).[131][132] The medication reportedly has no birth control effect.[133]
It has been suggested that the weak progestogenic activity of spironolactone is responsible for these effects, although this has not been established and spironolactone has been shown to possess insignificant progestogenic and antiprogestogenic activity even at high dosages in women.[83][134][135] An alternative proposed cause is inhibition of 17α-hydroxylase and hence sex steroid metabolism by spironolactone and consequent changes in sex hormone levels.[105] Indeed, CYP17A1 genotype is associated with polymenorrhea.[136] Regardless of their mechanism, the menstrual disturbances associated with spironolactone can usually be controlled well by concomitant treatment with a birth control pill, due to the progestin component.[83][137]
Mood changes
Research is mixed on whether antimineralocorticoids like spironolactone have positive or negative effects on mood.[138][139][140] In any case, it is possible that spironolactone might have the capacity to increase the risk of depressive symptoms.[138][139][140] However, a 2017 hybrid systematic review found that the incidence of depression in women treated with spironolactone for acne was less than 1%.[60] Likewise, a 10-year observational study found that the incidence of depression in 196 transgender women taking high-dose spironolactone in combination with an estrogen was less than 1%.[141]
Lipid changes
Spironolactone has been found to increase LDL ("bad") cholesterol and decrease HDL ("good") cholesterol levels at the relatively high doses used in women with polycystic ovary syndrome (PCOS).[142][143] As such, it may have unfavorable effects on the blood lipid profile in this context.[142][143] Heightened LDL cholesterol levels are a potential risk factor for cardiovascular disease such as atherosclerosis or coronary heart disease.[144] Consequently, it has been said that spironolactone should not be given to women with dyslipidemia (e.g., high cholesterol).[142][143] Unfavorable lipid changes have also been seen with other antiandrogens, like cyproterone acetate[145][146] and bicalutamide.[147][81]
Rare reactions
Aside from hyperkalemia, spironolactone may rarely cause adverse reactions such as anaphylaxis, kidney failure,[148] hepatitis (two reported cases, neither serious),[149] agranulocytosis, DRESS syndrome, Stevens–Johnson syndrome or toxic epidermal necrolysis.[150][151] Five cases of breast cancer in patients who took spironolactone for prolonged periods of time have been reported.[106][125]
Spironolactone bodies
Long-term administration of spironolactone gives the histologic characteristic of "spironolactone bodies" in the adrenal cortex. Spironolactone bodies are eosinophilic, round, concentrically laminated cytoplasmic inclusions surrounded by clear halos in preparations stained with hematoxylin and eosin.[152]
Pregnancy and breastfeeding
In the United States, spironolactone is considered pregnancy category C meaning that it is unclear if it is safe for use during pregnancy.[3][4] It is able to cross the placenta.[121] Likewise, it has been found to be present in the breast milk of lactating mothers and, while the effects of spironolactone or its metabolites have not been extensively studied in breastfeeding infants, it is generally recommended that women also not take the medication while nursing.[8] However, only very small amounts of spironolactone and its metabolite canrenone enter breast milk, and the amount received by an infant during breastfeeding (<0.5% of the mother's dose) is considered to be insignificant.[153]
A study found that spironolactone was not associated with teratogenicity in the offspring of rats.[154][155][156] Because it is an antiandrogen, however, spironolactone could theoretically have the potential to cause feminization of male fetuses at sufficient doses.[154][155] In accordance, a subsequent study found that partial feminization of the genitalia occurred in the male offspring of rats that received doses of spironolactone that were five times higher than those normally used in humans (200 mg/kg per day).[154][156] Another study found permanent, dose-related reproductive tract abnormalities rat offspring of both sexes at lower doses (50 to 100 mg/kg per day).[156]
In practice however, although experience is limited, spironolactone has never been reported to cause observable feminization or any other congenital defects in humans.[154][155][157][158] Among 31 human newborns exposed to spironolactone in the first trimester, there were no signs of any specific birth defects.[158] A case report described a woman who was prescribed spironolactone during pregnancy with triplets and delivered all three (one boy and two girls) healthy; there was no feminization in the boy.[158] In addition, spironolactone has been used at high doses to treat pregnant women with Bartter's syndrome, and none of the infants (three boys, two girls) showed toxicity, including feminization in the male infants.[153][154] There are similar findings, albeit also limited, for another antiandrogen, cyproterone acetate (prominent genital defects in male rats, but no human abnormalities (including feminization of male fetuses) at both a low dose of 2 mg/day or high doses of 50 to 100 mg/day).[158] In any case, spironolactone is nonetheless not recommended during pregnancy due to theoretical concerns relating to feminization of males and also to potential alteration of fetal potassium levels.[154][159]
A 2019 systematic review found insufficient evidence that spironolactone causes birth defects in humans.[160] However, there was also insufficient evidence to be certain that it does not.[160]
Overdose
Spironolactone is relatively safe in acute overdose.[8] Symptoms following an acute overdose of spironolactone may include drowsiness, confusion, maculopapular or erythematous rash, nausea, vomiting, dizziness, and diarrhea.[8] In rare cases, hyponatremia, hyperkalemia, or hepatic coma may occur in individuals with severe liver disease.[8] However, these adverse reactions are unlikely in the event of an acute overdose.[8] Hyperkalemia can occur following an overdose of spironolactone, and this is especially so in people with decreased kidney function.[8] Spironolactone has been studied at extremely high oral doses of up to 2,400 mg per day in clinical trials.[102][161] Its oral median lethal dose (LD50) is more than 1,000 mg/kg in mice, rats, and rabbits.[8]
There is no specific antidote for overdose of spironolactone.[8] Treatment may consist of induction of vomiting or stomach evacuation by gastric lavage.[8] The treatment of spironolactone overdose is supportive, with the purpose of maintaining hydration, electrolyte balance, and vital functions.[8] Spironolactone should be discontinued in people with impaired kidney function or hyperkalemia.[8]
Interactions
Spironolactone often increases serum potassium levels and can cause hyperkalemia, a very serious condition. Therefore, it is recommended that people using this medication avoid potassium supplements and salt substitutes containing potassium.[162] Physicians must be careful to monitor potassium levels in both males and females who are taking spironolactone as a diuretic, especially during the first twelve months of use and whenever the dosage is increased. Doctors may also recommend that some patients may be advised to limit dietary consumption of potassium-rich foods. However, recent data suggests that both potassium monitoring and dietary restriction of potassium intake is unnecessary in healthy young women taking spironolactone for acne.[120] Spironolactone together with trimethoprim/sulfamethoxazole increases the likelihood of hyperkalemia, especially in the elderly. The trimethoprim portion acts to prevent potassium excretion in the distal tubule of the nephron.[163]
Spironolactone has been reported to induce the enzymes CYP3A4 and certain UDP-glucuronosyltransferases (UGTs), which can result in interactions with various medications.[15][164][165] However, it has also been reported that metabolites of spironolactone irreversibly inhibit CYP3A4.[166] In any case, spironolactone has been found to reduce the bioavailability of oral estradiol, which could be due to induction of estradiol metabolism via CYP3A4.[167] Spironolactone has also been found to inhibit UGT2B7.[168] Spironolactone can also have numerous other interactions, most commonly with other cardiac and blood pressure medications, for instance digoxin.[8]
Licorice, which has indirect mineralocorticoid activity by inhibiting mineralocorticoid metabolism, has been found to inhibit the antimineralocorticoid effects of spironolactone.[169][170][171] Moreover, the addition of licorice to spironolactone has been found to reduce the antimineralocorticoid side effects of spironolactone in women treated with it for hyperandrogenism, and licorice hence may be used to reduce these side effects in women treated with spironolactone as an antiandrogen who are bothered by them.[169][170] On the opposite end of the spectrum, spironolactone is useful in reversing licorice-induced hypokalemia.[172][173] Aspirin and other nonsteroidal anti-inflammatory drugs (NSAIDs) have been found to attenuate the diuresis and natriuresis induced by spironolactone, but, not to affect its antihypertensive effect.[34][174]
Some research has suggested that spironolactone might be able to interfere with the effectiveness of antidepressant treatment. As the medication acts as an antimineralocorticoid, it is thought that it might be able to reduce the effectiveness of certain antidepressants by interfering with normalization of the hypothalamic–pituitary–adrenal axis and by increasing levels of glucocorticoids such as cortisol.[175][176] However, other research contradicts this hypothesis and has suggested that spironolactone might actually produce antidepressant effects, for instance studies showing antidepressant-like effects of spironolactone in animals.[177]
Pharmacology
Pharmacodynamics


The pharmacodynamics of spironolactone are characterized by high antimineralocorticoid activity, moderate antiandrogenic activity, and weak steroidogenesis inhibition, among other more minor activities.[102][104][127] Spironolactone is a prodrug, so most of its actions are actually mediated by its various active metabolites.[102] The major active forms of spironolactone are 7α-thiomethylspironolactone (7α-TMS) and canrenone (7α-desthioacetyl-δ6-spironolactone).[11][102]
Spironolactone is a potent antimineralocorticoid.[11] That is, it is an antagonist of the mineralocorticoid receptor (MR), the biological target of mineralocorticoids like aldosterone and 11-deoxycorticosterone.[11] By blocking the MR, spironolactone inhibits the effects of mineralocorticoids in the body.[11] The antimineralocorticoid activity of spironolactone is responsible for its therapeutic efficacy in the treatment of edema, high blood pressure, heart failure, hyperaldosteronism, and ascites due to cirrhosis.[181][182] It is also responsible for many of the side effects of spironolactone, such as urinary frequency, dehydration, hyponatremia, low blood pressure, fatigue, dizziness, metabolic acidosis, decreased kidney function, and its risk of hyperkalemia.[183] Due to the antimineralocorticoid activity of spironolactone, levels of aldosterone are significantly increased by the medication, probably reflecting an attempt of the body to maintain homeostasis.[57][83]
Spironolactone is a moderate antiandrogen.[104][134][165] That is, it is an antagonist of the androgen receptor (AR), the biological target of androgens like testosterone and dihydrotestosterone (DHT).[104][134][165] By blocking the AR, spironolactone inhibits the effects of androgens in the body.[104][134][165] The antiandrogenic activity of spironolactone is mainly responsible for its therapeutic efficacy in the treatment of androgen-dependent skin and hair conditions like acne, seborrhea, hirsutism, and pattern hair loss and hyperandrogenism in women, precocious puberty in boys with testotoxicosis, and as a component of feminizing hormone therapy for transgender women.[134][167][184] It is also primarily responsible for some of its side effects, like breast tenderness, gynecomastia, feminization, and demasculinization in men.[105][184] Blockade of androgen signaling in the breast disinhibits the actions of estrogens in this tissue.[185] Although useful as an antiandrogen in women, who have low testosterone levels compared to men,[186][187] spironolactone is described as having relatively weak antiandrogenic activity.[188][184][189][190]
Spironolactone is a weak steroidogenesis inhibitor.[104][127][134][191] That is, it inhibits steroidogenic enzymes, or enzymes involved in the production of steroid hormones.[104][127][134][191] Spironolactone and/or its metabolites have been found in vitro to weakly inhibit a broad array of steroidogenic enzymes including cholesterol side-chain cleavage enzyme, 17α-hydroxylase, 17,20-lyase, 5α-reductase, 3β-hydroxysteroid dehydrogenase, 11β-hydroxylase, 21-hydroxylase, and aldosterone synthase (18-hydroxylase).[134][191][192][193] However, although very high doses of spironolactone can considerably decrease steroid hormone levels in animals, spironolactone has shown mixed and inconsistent effects on steroid hormone levels in clinical studies, even at high clinical doses.[60][104][127][134][165] In any case, the levels of most steroid hormones, including testosterone and cortisol, are usually unchanged by spironolactone in humans, which may in part be related to compensatory upregulation of their synthesis.[104][127][194] The weak steroidogenesis inhibition of spironolactone might contribute to its antiandrogenic efficacy to some degree and may explain its side effect of menstrual irregularities in women.[104][105] However, its androgen synthesis inhibition is probably clinically insignificant.[63]
Spironolactone has been found in some studies to increase levels of estradiol, an estrogen, although many other studies have found no changes in estradiol levels.[104][127] The mechanism of how spironolactone increases estradiol levels is unclear, but it may involve inhibition of the inactivation of estradiol into estrone and enhancement of the peripheral conversion of testosterone into estradiol.[195][196] It is notable that spironolactone has been found in vitro to act as a weak inhibitor of 17β-hydroxysteroid dehydrogenase 2, an enzyme that is involved in the conversion of estradiol into estrone.[197][198] Increased levels of estradiol with spironolactone may be involved in its preservation of bone density and in its side effects such as breast tenderness, breast enlargement, and gynecomastia in women and men.[195][199][200]
In response to the antimineralocorticoid activity spironolactone, and in an attempt to maintain homeostasis, the body increases aldosterone production in the adrenal cortex.[201][202][203] Some studies have found that levels of cortisol, a glucocorticoid hormone that is also produced in the adrenal cortex, are increased as well.[202][203][204] However, other clinical studies have found no change in cortisol levels with spironolactone,[134][205][94][206] and those that have found increases often have observed only small changes.[207] In accordance, spironolactone has not been associated with conventional glucocorticoid medication effects or side effects.[208][209]
Other activities of spironolactone may include very weak interactions with the estrogen and progesterone receptors and agonism of the pregnane X receptor.[94][210] These activities could contribute to the menstrual irregularities and breast side effects of spironolactone and to its drug interactions, respectively.[211][212][213]
Pharmacokinetics
The pharmacokinetics of spironolactone have not been studied well, which is in part because it is an old medication that was developed in the 1950s.[128] Nonetheless, much has been elucidated about the pharmacokinetics of spironolactone over the decades.[214][215][216][11][217][218][219][220]
Absorption

The bioavailability of spironolactone when taken by mouth is 60 to 90%.[11][12][13] The bioavailability of spironolactone and its metabolites increases significantly (+22–95% increases in levels) when spironolactone is taken with food, although it is uncertain whether this further increases the therapeutic effects of the medication.[222][223][224] The increase in bioavailability is thought to be due to promotion of the gastric dissolution and absorption of spironolactone, as well as due to a decrease of the first-pass metabolism.[222][225][226] The relationship between a single dose of spironolactone and plasma levels of canrenone, a major active metabolite of spironolactone, has been found to be linear across a dose range of 25 to 200 mg spironolactone.[188] Steady-state concentrations of spironolactone are achieved within 8 to 10 days of treatment initiation.[179][227]
Little or no systemic absorption has been observed with topical spironolactone.[228]
Distribution
Spironolactone and its metabolite canrenone are highly plasma protein bound, with percentages of 88.0% and 99.2%, respectively.[11][14] Spironolactone is bound equivalently to albumin and α1-acid glycoprotein, while canrenone is bound only to albumin.[11][14] Spironolactone and its metabolite 7α-thiospironolactone show very low or negligible affinity for sex hormone-binding globulin (SHBG).[229][230] In accordance, a study of high-dosage spironolactone treatment found no change in steroid binding capacity related to SHBG or to corticosteroid-binding globulin (CBG), suggesting that spironolactone does not displace steroid hormones from their carrier proteins.[231] This is in contradiction with widespread statements that spironolactone increases free estradiol levels by displacing estradiol from SHBG.[94][232]
Spironolactone appears to cross the blood–brain barrier.[233][234]
Metabolism

Spironolactone is rapidly and extensively metabolized in the liver upon oral administration and has a very short terminal half-life of 1.4 hours.[11][12] The major metabolites of spironolactone are 7α-thiomethylspironolactone (7α-TMS), 6β-hydroxy-7α-thiomethylspironolactone (6β-OH-7α-TMS), and canrenone (7α-desthioacetyl-δ6-spironolactone).[11][12][178] These metabolites have much longer elimination half-lives than spironolactone of 13.8 hours, 15.0 hours, and 16.5 hours, respectively, and are responsible for the therapeutic effects of the medication.[11][12] As such, spironolactone is a prodrug.[236] The 7α-thiomethylated metabolites of spironolactone were not known for many years and it was originally thought that canrenone was the major active metabolite of the medication, but subsequent research identified 7α-TMS as the major metabolite.[11][178][179] Other known but more minor metabolites of spironolactone include 7α-thiospironolactone (7α-TS), which is an important intermediate to the major metabolites of spironolactone,[15] as well as the 7α-methyl ethyl ester of spironolactone and the 6β-hydroxy-7α-methyl ethyl ester of spironolactone.[20]
Spironolactone is hydrolyzed or deacetylated at the thioester of the C7α position into 7α-TS by carboxylesterases.[15][237] Following formation of 7α-TS, it is S-oxygenated by flavin-containing monooxygenases to form an electrophilic sulfenic acid metabolite.[15] This metabolite is involved in the CYP450 inhibition of spironolactone, and also binds covalently to other proteins.[15] 7α-TS is also S-methylated into 7α-TMS, a transformation catalyzed by thiol S-methyltransferase.[15] Unlike the related medication eplerenone, spironolactone is said to not be metabolized by CYP3A4.[238] However, hepatic CYP3A4 is likely responsible for the 6β-hydroxylation of 7α-TMS into 6β-OH-7α-TMS.[16][239] 7α-TMS may also be hydroxylated at the C3α and C3β positions.[17] Spironolactone is dethioacetylated into canrenone.[18] Finally, the C17 γ-lactone ring of spironolactone is hydrolyzed by the paraoxonase PON3.[19][240] It was originally thought to be hydrolyzed by PON1, but this was due to contamination with PON3.[19]
| Compound | Cmax (day 1) | Cmax (day 15) | AUC (day 15) | t1/2 |
|---|---|---|---|---|
| Spironolactone | 72 ng/mL (173 nmol/L) | 80 ng/mL (192 nmol/L) | 231 ng•hour/mL (555 nmol•hour/L) | 1.4 hours |
| Canrenone | 155 ng/mL (455 nmol/L) | 181 ng/mL (532 nmol/L) | 2,173 ng•hour/mL (6,382 nmol•hour/L) | 16.5 hours |
| 7α-TMS | 359 ng/mL (924 nmol/L) | 391 ng/mL (1,006 nmol/L) | 2,804 ng•hour/mL (7,216 nmol•hour/L) | 13.8 hours |
| 6β-OH-7α-TMS | 101 ng/mL (250 nmol/L) | 125 ng/mL (309 nmol/L) | 1,727 ng•hour/mL (4,269 nmol•hour/L) | 15.0 hours |
| Sources: See template. | ||||
Elimination
The majority of spironolactone is eliminated by the kidneys, while minimal amounts are handled by biliary excretion.[241]
Chemistry
Spironolactone, also known as 7α-acetylthiospirolactone, is a steroidal 17α-spirolactone, or more simply a spirolactone.[102] It can most appropriately be conceptualized as a derivative of progesterone,[126][242][227] itself also a potent antimineralocorticoid, in which a hydroxyl group has been substituted at the C17α position (as in 17α-hydroxyprogesterone), the acetyl group at the C17β position has been cyclized with the C17α hydroxyl group to form a spiro 21-carboxylic acid γ-lactone ring, and an acetylthio group has been substituted in at the C7α position.[243][244][245] These structural modifications of progesterone confer increased oral bioavailability and potency,[246] potent antiandrogenic activity, and strongly reduced progestogenic activity.[247] The C7α substitution is likely responsible for or involved in the antiandrogenic activity of spironolactone, as 7α-thioprogesterone (SC-8365), unlike progesterone,[248] is an antiandrogen with similar affinity to the AR as that of spironolactone.[249] In addition, the C7α substitution appears to be responsible for the loss of progestogenic activity and good oral bioavailability of spironolactone, as SC-5233, the analogue of spironolactone without a C7α substitution, has potent progestogenic activity but very poor oral bioavailability similarly to progesterone.[248][250][251]
Names
Spironolactone is also known by the following equivalent chemical names:[243][244][245]
- 7α-Acetylthio-17α-hydroxy-3-oxopregn-4-ene-21-carboxylic acid γ-lactone
- 7α-Acetylthio-3-oxo-17α-pregn-4-ene-21,17β-carbolactone
- 3-(3-Oxo-7α-acetylthio-17β-hydroxyandrost-4-en-17α-yl)propionic acid lactone
- 7α-Acetylthio-17α-(2-carboxyethyl)androst-4-en-17β-ol-3-one γ-lactone
- 7α-Acetylthio-17α-(2-carboxyethyl)testosterone γ-lactone
Analogues
Chemical structures of spirolactones
|
Spironolactone is closely related structurally to other clinically used spirolactones such as canrenone, potassium canrenoate, drospirenone, and eplerenone, as well as to the never-marketed spirolactones SC-5233 (6,7-dihydrocanrenone; 7α-desthioacetylspironolactone), SC-8109 (19-nor-6,7-dihydrocanrenone), spiroxasone, prorenone (SC-23133), mexrenone (SC-25152, ZK-32055), dicirenone (SC-26304), spirorenone (ZK-35973), and mespirenone (ZK-94679).[102]
Synthesis
Chemical syntheses of spironolactone and its analogues and derivatives have been described and reviewed.[252]
History
The natriuretic effects of progesterone were demonstrated in 1955, and the development of spironolactone as a synthetic antimineralocorticoid analogue of progesterone shortly followed this.[126][242][253][254] Spironolactone was first synthesized in 1957,[25][253][254] was patented between 1958 and 1961,[255][256] and was first marketed, as an antimineralocorticoid, in 1959.[257][258] Gynecomastia was first reported with spironolactone in 1962,[102][259] and the antiandrogenic activity of the medication was first described in 1969.[260] This shortly followed the discovery in 1967 that gynecomastia is an important and major side effect of AR antagonists.[261][262] Spironolactone was first studied in the treatment of hirsutism in women in 1978.[263][169][264][265][266] It has since become the most widely used antiandrogen for dermatological indications in women in the United States.[98][267][268][269] Spironolactone was first studied as an antiandrogen in transgender women in 1986, and has since become widely adopted for this purpose as well, particularly in the United States where cyproterone acetate is not available.[270][271][272]
Early oral spironolactone tablets showed poor absorption.[273] The formulation was eventually changed to a micronized formulation with particle sizes of less than 50 μg, which resulted in approximately 4-fold increased potency.[273][274]
Society and culture
Generic names
The English, French, and generic name of the medication is spironolactone and this is its INN, USAN, USP, BAN, DCF, and JAN.[100][101][243][275] Its name is spironolactonum in Latin, spironolacton in German, espironolactona in Spanish and Portuguese, and spironolattone in Italian (which is also its DCIT).[100][101][275]
Spironolactone is also known by its developmental code names SC-9420 and NSC-150339.[100][101][243]
Brand names
Spironolactone is marketed under a large number of brand names throughout the world.[100][101] The major brand name of spironolactone is Aldactone.[100][101] Other important brand names include Aldactone-A, Berlactone, CaroSpir, Espironolactona, Espironolactona Genfar, Novo-Spiroton, Prilactone (veterinary), Spiractin, Spiridon, Spirix, Spiroctan, Spiroderm (discontinued),[5] Spirogamma, Spirohexal, Spirolon, Spirolone, Spiron, Spironolactone Actavis, Spironolactone Orion, Spironolactone Teva, Spirotone, Tempora (veterinary), Uractone, Uractonum, Verospiron, and Vivitar.[100][101]
Spironolactone is also formulated in combination with a variety of other medications, including with hydrochlorothiazide as Aldactazide, with hydroflumethiazide as Aldactide, Lasilacton, Lasilactone, and Spiromide, with altizide as Aldactacine and Aldactazine, with furosemide as Fruselac, with benazepril as Cardalis (veterinary), with metolazone as Metolactone, with bendroflumethiazide as Sali-Aldopur, and with torasemide as Dytor Plus, Torlactone, and Zator Plus.[101]
Availability
Spironolactone is marketed widely throughout the world and is available in almost every country, including in the United States, Canada, the United Kingdom, other European countries, Australia, New Zealand, South Africa, Central and South America, and East and Southeast Asia.[100][101]
Usage
There was a total of 17.2 million prescriptions for spironolactone in the United States between the beginning of 2003 and the end of 2005.[276] There was a total of 12.0 million prescriptions for spironolactone in the United States in 2016 alone.[277] It was the 66th top prescribed medication in the United States in 2016.[277]
Research
Prostate conditions
Spironolactone has been studied at a high dosage in the treatment of benign prostatic hyperplasia (BPH; enlarged prostate).[278][279][280] It was found to be better than placebo in terms of symptom relief following three months of treatment.[278][279] However, this was not maintained after six months of treatment, by which point the improvements had largely disappeared.[278][279][280] Moreover, no difference was observed between spironolactone and placebo with regard to volume of residual urine or prostate size.[278][279] Gynecomastia was observed in about 5% of people.[279] On the basis of these results, it has been said that spironolactone has no place in the treatment of BPH.[279]
Spironolactone has been studied and used limitedly in the treatment of prostate cancer.[281][282][34]
Epstein–Barr virus
Spironolactone has been found to block Epstein–Barr virus (EBV) production and that of other human herpesviruses by inhibiting the function of an EBV protein SM, which is essential for infectious virus production.[283] This effect of spironolactone was determined to be independent of its antimineralocorticoid actions.[283] Thus, spironolactone or compounds based on it have the potential to yield novel antiviral medications with a distinct mechanism of action and limited toxicity.[283]
Other conditions
Spironolactone has been studied in the treatment of rosacea in both males and females.[284][285][286][71][287]
Spironolactone has been studied in fibromyalgia in women.[288][289] It has also been studied in bulimia nervosa in women, but was not found to be effective.[290]
References
- ↑ Loughlin KR, Generali JA (2006). The Guide to Off-label Prescription Drugs: New Uses for FDA-approved Prescription Drugs. Simon and Schuster. pp. 131–. ISBN 978-0-7432-8667-1. Archived from the original on 7 October 2022. Retrieved 6 November 2016.
- ↑ Clark MA, Harvey RA, Finkel R, Rey JA, Whalen K (15 December 2011). Pharmacology. Lippincott Williams & Wilkins. pp. 286, 337. ISBN 978-1-4511-1314-3. Archived from the original on 7 October 2022. Retrieved 6 November 2016.
- 1 2 3 "Spironolactone Pregnancy and Breastfeeding Warnings". Archived from the original on 2 December 2015. Retrieved 29 November 2015.
- 1 2 3 4 5 6 7 8 9 10 "Spironolactone". The American Society of Health-System Pharmacists. Archived from the original on 16 November 2015. Retrieved 24 October 2015.
- 1 2 3 Farid NR, Diamanti-Kandarakis E (27 February 2009). Diagnosis and Management of Polycystic Ovary Syndrome. Springer Science & Business Media. pp. 235–. ISBN 978-0-387-09718-3. Archived from the original on 7 October 2022. Retrieved 6 November 2016.
- ↑ "Aldactone 25 mg Film-Coated TabletsSummary of Product Characteristics (SmPC)". (emc). 3 February 2022. Archived from the original on 6 October 2022. Retrieved 2 August 2023.
- ↑ "FDA-sourced list of all drugs with black box warnings (Use Download Full Results and View Query links.)". nctr-crs.fda.gov. FDA. Retrieved 22 October 2023.
- 1 2 3 4 5 6 7 8 9 10 11 12 13 14 15 16 17 18 19 "Aldactone- spironolactone tablet, film coated". DailyMed. 29 November 2018. Archived from the original on 10 September 2015. Retrieved 1 January 2020.
- ↑ "Qaialdo EPAR". European Medicines Agency (EMA). 25 July 2023. Archived from the original on 27 July 2023. Retrieved 2 August 2023.
- ↑ "Qaialdo". Union Register of medicinal products. 31 May 2023. Archived from the original on 6 June 2023. Retrieved 6 June 2023.
- 1 2 3 4 5 6 7 8 9 10 11 12 13 14 15 16 17 18 19 20 21 Sica DA (January 2005). "Pharmacokinetics and pharmacodynamics of mineralocorticoid blocking agents and their effects on potassium homeostasis". Heart Failure Reviews. 10 (1): 23–9. doi:10.1007/s10741-005-2345-1. PMID 15947888. S2CID 21437788.
- 1 2 3 4 5 6 7 8 Maron BA, Leopold JA (September 2008). "Mineralocorticoid receptor antagonists and endothelial function". Current Opinion in Investigational Drugs. 9 (9): 963–9. PMC 2967484. PMID 18729003.
- 1 2 Carone L, Oxberry SG, Twycross R, Charlesworth S, Mihalyo M, Wilcock A (February 2017). "Spironolactone". Journal of Pain and Symptom Management. 53 (2): 288–292. doi:10.1016/j.jpainsymman.2016.12.320. PMID 28024992.
- 1 2 3 4 Takamura N, Maruyama T, Ahmed S, Suenaga A, Otagiri M (April 1997). "Interactions of aldosterone antagonist diuretics with human serum proteins". Pharmaceutical Research. 14 (4): 522–6. doi:10.1023/A:1012168020545. PMID 9144743. S2CID 13227538.
- 1 2 3 4 5 6 7 Parkinson A (2001). Biotransformation of Xenobiotics. McGraw-Hill. pp. 137–138, 169, 171, 180, 195, 208. Archived from the original on 7 October 2022. Retrieved 12 August 2018.
- 1 2 Klaassen CD (11 December 2007). Casarett & Doull's Toxicology: The Basic Science of Poisons, Seventh Edition. McGraw Hill Professional. p. 173. ISBN 978-0-07-159351-9. Archived from the original on 7 October 2022. Retrieved 12 August 2018.
Some P450 enzymes (such as the rate enzyme CYP2A1) preferentially catalyze the 6α-hydroxylation reaction, whereas other P450 enzymes (such as the CYP3A enzymes in all mammalian species) preferentially catalyze the 6β-hydroxylation reaction (which is a major route of hepatic steroid biotransformation).
- 1 2 Los LE, Pitzenberger SM, Ramjit HG, Coddington AB, Colby HD (1994). "Hepatic metabolism of spironolactone. Production of 3-hydroxy-thiomethyl metabolites". Drug Metabolism and Disposition. 22 (6): 903–8. PMID 7895608.
- 1 2 Black HR, Elliott W (28 December 2006). Hypertension: A Companion to Braunwald's Heart Disease. Elsevier Health Sciences. pp. 295–. ISBN 978-1-4377-1078-6. Archived from the original on 7 October 2022. Retrieved 12 August 2018.
- 1 2 3 Draganov DI, La Du BN (January 2004). "Pharmacogenetics of paraoxonases: a brief review". Naunyn-Schmiedeberg's Archives of Pharmacology. 369 (1): 78–88. doi:10.1007/s00210-003-0833-1. hdl:2027.42/46312. PMID 14579013. S2CID 15825605.
- 1 2 Szasz G, Budvari-Barany Z (19 December 1990). Pharmaceutical Chemistry of Antihypertensive Agents. CRC Press. pp. 91–. ISBN 978-0-8493-4724-5.
- ↑ McDonagh TA, Gardner RS, Clark AL, Dargie H (14 July 2011). Oxford Textbook of Heart Failure. OUP Oxford. pp. 403–. ISBN 978-0-19-957772-9. Archived from the original on 27 March 2017.
- ↑ Friedman AJ (October 2015). "Spironolactone for Adult Female Acne". Cutis. 96 (4): 216–7. PMID 27141564.
- ↑ Maizes V (2015). Integrative Women's Health (2 ed.). Oxford University Press. p. 746. ISBN 978-0-19-021480-7.
- ↑ Deedwania PC (30 January 2014). Drug & Device Selection in Heart Failure. JP Medical Ltd. pp. 47–. ISBN 978-93-5090-723-8. Archived from the original on 7 October 2022. Retrieved 5 July 2017.
- 1 2 Ottow E, Weinmann H (9 July 2008). Nuclear Receptors As Drug Targets. John Wiley & Sons. p. 410. ISBN 978-3-527-62330-3. Archived from the original on 21 June 2013. Retrieved 28 May 2012.
- ↑ Wermuth CG (24 July 2008). The Practice of Medicinal Chemistry. Academic Press. p. 34. ISBN 978-0-12-374194-3. Archived from the original on 21 June 2013. Retrieved 27 May 2012.
- ↑ Sittig M (1988). Pharmaceutical Manufacturing Encyclopedia. William Andrew. p. 1385. ISBN 978-0-8155-1144-1. Archived from the original on 20 June 2013. Retrieved 27 May 2012.
- ↑ World Health Organization (2019). World Health Organization model list of essential medicines: 21st list 2019. Geneva: World Health Organization. hdl:10665/325771. WHO/MVP/EMP/IAU/2019.06. License: CC BY-NC-SA 3.0 IGO.
- ↑ World Health Organization (2021). World Health Organization model list of essential medicines: 22nd list (2021). Geneva: World Health Organization. hdl:10665/345533. WHO/MHP/HPS/EML/2021.02.
- ↑ "The Top 300 of 2020". ClinCalc. Archived from the original on 13 April 2021. Retrieved 7 October 2022.
- ↑ "Spironolactone - Drug Usage Statistics". ClinCalc. Archived from the original on 29 April 2017. Retrieved 7 October 2022.
- 1 2 3 4 Ronco C, Bellomo R, Kellum JA, Ricci Z (14 December 2017). Critical Care Nephrology E-Book. Elsevier Health Sciences. pp. 371–. ISBN 978-0-323-51199-5. Archived from the original on 7 October 2022. Retrieved 17 August 2018.
- ↑ Delyani JA (April 2000). "Mineralocorticoid receptor antagonists: the evolution of utility and pharmacology". Kidney International. 57 (4): 1408–11. doi:10.1046/j.1523-1755.2000.00983.x. PMID 10760075.
When spironolactone was developed nearly 30 years ago, the scientific study of aldosterone was limited to effects on epithelial ion transport, and even this knowledge was in its infancy. As a result, spironolactone was classified as a potassium-sparing diuretic. Given that the compelling evidence of the role of aldosterone in the pathophysiology of cardiovascular disease extends beyond ion transport, this classification is presently obsolete.
- 1 2 3 Endou H, Hosoyamada M (1995). "Potassium-Retaining Diuretics: Aldosterone Antagonists". Diuretics. Handbook of Experimental Pharmacology. Vol. 117. pp. 335–361. doi:10.1007/978-3-642-79565-7_9. ISBN 978-3-642-79567-1. ISSN 0171-2004.
- 1 2 Hughes BR, Cunliffe WJ (May 1988). "Tolerance of spironolactone". The British Journal of Dermatology. 118 (5): 687–91. doi:10.1111/j.1365-2133.1988.tb02571.x. PMID 2969259. S2CID 208286107.
- ↑ Preedy VR (1 January 2012). Handbook of Hair in Health and Disease. Springer Science & Business Media. pp. 132–. ISBN 978-90-8686-728-8. Archived from the original on 7 October 2022. Retrieved 6 October 2016.
- ↑ Loy R, Seibel MM (December 1988). "Evaluation and therapy of polycystic ovarian syndrome". Endocrinology and Metabolism Clinics of North America. 17 (4): 785–813. doi:10.1016/S0889-8529(18)30410-9. PMID 3143568.
- ↑ Yancy CW, Jessup M, Bozkurt B, Butler J, Casey DE, Drazner MH, et al. (October 2013). "2013 ACCF/AHA guideline for the management of heart failure: a report of the American College of Cardiology Foundation/American Heart Association Task Force on Practice Guidelines". Journal of the American College of Cardiology. 62 (16): e147-239. doi:10.1016/j.jacc.2013.05.019. PMID 23747642.
- ↑ Li S, Zhang X, Dong M, Gong S, Shang Z, Jia X, et al. (August 2018). "Effects of spironolactone in heart failure with preserved ejection fraction: A meta-analysis of randomized controlled trials". Medicine. 97 (35): e11942. doi:10.1097/MD.0000000000011942. PMC 6392615. PMID 30170387.
- ↑ Kosmas CE, Silverio D, Sourlas A, Montan PD, Guzman E (December 2018). "Role of spironolactone in the treatment of heart failure with preserved ejection fraction". Annals of Translational Medicine. 6 (23): 461. doi:10.21037/atm.2018.11.16. PMC 6312809. PMID 30603649.
- ↑ Chatterjee S, Moeller C, Shah N, Bolorunduro O, Lichstein E, Moskovits N, Mukherjee D (August 2012). "Eplerenone is not superior to older and less expensive aldosterone antagonists". The American Journal of Medicine. 125 (8): 817–25. doi:10.1016/j.amjmed.2011.12.018. PMID 22840667.
- 1 2 Batterink J, Stabler SN, Tejani AM, Fowkes CT (August 2010). "Spironolactone for hypertension". The Cochrane Database of Systematic Reviews (8): CD008169. doi:10.1002/14651858.CD008169.pub2. PMID 20687095.
- 1 2 3 4 Stavropoulos K, Papadopoulos C, Koutsampasopoulos K, Lales G, Mitas C, Doumas M (2018). "Mineralocorticoid Receptor Antagonists in Primary Aldosteronism". Curr Pharm Des. 24 (46): 5508–5516. doi:10.2174/1381612825666190311130138. PMID 30854950. S2CID 73727928.
- ↑ Forestiero V, Sconfienza E, Mulatero P, Monticone S (May 2022). "Primary aldosteronism in pregnancy". Rev Endocr Metab Disord. 24 (1): 39–48. doi:10.1007/s11154-022-09729-6. PMC 9884655. PMID 35536535. S2CID 248574316.
- ↑ Landau E, Amar L (June 2016). "Primary aldosteronism and pregnancy". Ann Endocrinol (Paris). 77 (2): 148–60. doi:10.1016/j.ando.2016.04.009. PMID 27156905.
- ↑ Riester A, Reincke M (January 2015). "Progress in primary aldosteronism: mineralocorticoid receptor antagonists and management of primary aldosteronism in pregnancy". Eur J Endocrinol. 172 (1): R23–30. doi:10.1530/EJE-14-0444. PMID 25163723. S2CID 43338556.
- ↑ Araujo-Castro M (October 2020). "Treatment of primary hyperaldosteronism". Med Clin (Barc). 155 (7): 302–308. doi:10.1016/j.medcli.2020.04.029. PMID 32586668. S2CID 225657804.
- 1 2 Zouboulis CC, Degitz K (2004). "Androgen action on human skin -- from basic research to clinical significance". Experimental Dermatology. 13 (Suppl 4): 5–10. doi:10.1111/j.1600-0625.2004.00255.x. PMID 15507105. S2CID 34863608.
- 1 2 Endly DC, Miller RA (August 2017). "Oily Skin: A review of Treatment Options". The Journal of Clinical and Aesthetic Dermatology. 10 (8): 49–55. PMC 5605215. PMID 28979664.
- ↑ Shalita AR, Del Rosso JQ, Webster G (21 March 2011). Acne Vulgaris. CRC Press. pp. 33–. ISBN 978-1-61631-009-7. Archived from the original on 9 December 2016.
- ↑ Zouboulis CC, Katsambas AD, Kligman AM (28 July 2014). Pathogenesis and Treatment of Acne and Rosacea. Springer. pp. 121–. ISBN 978-3-540-69375-8. Archived from the original on 10 December 2016.
- ↑ Marks LS (2004). "5alpha-reductase: history and clinical importance". Reviews in Urology. 6 (Suppl 9): S11-21. PMC 1472916. PMID 16985920.
- ↑ Sloane E (2002). Biology of Women. Cengage Learning. pp. 160–. ISBN 978-0-7668-1142-3. Archived from the original on 7 October 2022. Retrieved 5 July 2017.
- ↑ Hanno PM, Guzzo TJ, Malkowicz SB, Wein AJ (26 January 2014). Penn Clinical Manual of Urology E-Book: Expert Consult - Online. Elsevier Health Sciences. pp. 782–. ISBN 978-0-323-24466-4. Archived from the original on 7 October 2022. Retrieved 5 July 2017.
- ↑ Harper C (1 August 2007). Intersex. Berg. pp. 123–. ISBN 978-1-84788-339-1. Archived from the original on 7 October 2022. Retrieved 5 July 2017.
- ↑ Blume-Peytavi U, Whiting DA, Trüeb RM (26 June 2008). Hair Growth and Disorders. Springer Science & Business Media. pp. 161–162. ISBN 978-3-540-46911-7. Archived from the original on 7 October 2022. Retrieved 16 July 2017.
- 1 2 3 4 5 6 Diamanti-Kandarakis E, Tolis G, Duleba AJ (1995). "Androgens and therapeutic aspects of antiandrogens in women". Journal of the Society for Gynecologic Investigation. 2 (4): 577–92. doi:10.1177/107155769500200401. PMID 9420861. S2CID 32242838.
- 1 2 Katsambas AD, Dessinioti C (2010). "Hormonal therapy for acne: why not as first line therapy? facts and controversies". Clinics in Dermatology. 28 (1): 17–23. doi:10.1016/j.clindermatol.2009.03.006. PMID 20082945.
- 1 2 3 4 5 6 7 8 9 10 Kim GK, Del Rosso JQ (March 2012). "Oral Spironolactone in Post-teenage Female Patients with Acne Vulgaris: Practical Considerations for the Clinician Based on Current Data and Clinical Experience". The Journal of Clinical and Aesthetic Dermatology. 5 (3): 37–50. PMC 3315877. PMID 22468178.
- 1 2 3 4 5 6 7 8 9 10 11 12 13 14 15 16 17 18 19 20 Layton AM, Eady EA, Whitehouse H, Del Rosso JQ, Fedorowicz Z, van Zuuren EJ (April 2017). "Oral Spironolactone for Acne Vulgaris in Adult Females: A Hybrid Systematic Review". American Journal of Clinical Dermatology. 18 (2): 169–191. doi:10.1007/s40257-016-0245-x. PMC 5360829. PMID 28155090.
- ↑ Santer M, Lawrence M, Renz S, Eminton Z, Stuart B, Sach TH, et al. (May 2023). "Effectiveness of spironolactone for women with acne vulgaris (SAFA) in England and Wales: pragmatic, multicentre, phase 3, double blind, randomised controlled trial". BMJ. 381: e074349. doi:10.1136/bmj-2022-074349. PMC 10543374. PMID 37192767. S2CID 258717921.
- 1 2 3 4 5 6 Zaenglein AL, Pathy AL, Schlosser BJ, Alikhan A, Baldwin HE, Berson DS, et al. (May 2016). "Guidelines of care for the management of acne vulgaris". Journal of the American Academy of Dermatology. 74 (5): 945–73.e33. doi:10.1016/j.jaad.2015.12.037. PMID 26897386.
- 1 2 3 4 Shaw JC (October 1996). "Antiandrogen and hormonal treatment of acne". Dermatologic Clinics. 14 (4): 803–11. doi:10.1016/S0733-8635(05)70405-8. PMID 9238337.
- 1 2 3 4 5 6 Somani N, Turvy D (July 2014). "Hirsutism: an evidence-based treatment update". American Journal of Clinical Dermatology. 15 (3): 247–66. doi:10.1007/s40257-014-0078-4. PMID 24889738. S2CID 45234892.
- 1 2 Rathnayake D, Sinclair R (2010). "Use of spironolactone in dermatology". Skinmed. 8 (6): 328–32, quiz 333. PMID 21413648.
- ↑ Harfmann KL, Bechtel MA (March 2015). "Hair loss in women". Clinical Obstetrics and Gynecology. 58 (1): 185–99. doi:10.1097/GRF.0000000000000081. PMID 25517757. S2CID 20364810.
- ↑ Cousen P, Messenger A (May 2010). "Female pattern hair loss in complete androgen insensitivity syndrome". The British Journal of Dermatology. 162 (5): 1135–7. doi:10.1111/j.1365-2133.2010.09661.x. PMID 20128792. S2CID 205259907.
- 1 2 Iswaran TJ, Imai M, Betton GR, Siddall RA (May 1997). "An overview of animal toxicology studies with bicalutamide (ICI 176,334)". The Journal of Toxicological Sciences. 22 (2): 75–88. doi:10.2131/jts.22.2_75. PMID 9198005.
- 1 2 Smith RE (4 April 2013). Medicinal Chemistry – Fusion of Traditional and Western Medicine. Bentham Science Publishers. pp. 306–. ISBN 978-1-60805-149-6. Archived from the original on 29 May 2016.
- ↑ Ostrzenski A (2002). Gynecology: Integrating Conventional, Complementary, and Natural Alternative Therapy. Lippincott Williams & Wilkins. pp. 86–. ISBN 978-0-7817-2761-7. Archived from the original on 6 October 2022. Retrieved 5 July 2017.
- 1 2 Schmidt JB (1998). "Other antiandrogens". Dermatology. 196 (1): 153–7. doi:10.1159/000017850. PMID 9557251. S2CID 22119267.
- 1 2 The World Professional Association for Transgender Health (WPATH) (2011). "Standards of Care for the Health of Transsexual, Transgender, and Gender Nonconforming People" (PDF). Archived from the original (PDF) on 23 May 2012. Retrieved 27 May 2012.
- 1 2 Hembree WC, Cohen-Kettenis P, Delemarre-van de Waal HA, Gooren LJ, Meyer WJ, Spack NP, et al. (September 2009). "Endocrine treatment of transsexual persons: an Endocrine Society clinical practice guideline". The Journal of Clinical Endocrinology and Metabolism. 94 (9): 3132–54. doi:10.1210/jc.2009-0345. PMID 19509099.
- 1 2 3 Prior JC, Vigna YM, Watson D (February 1989). "Spironolactone with physiological female steroids for presurgical therapy of male-to-female transsexualism". Archives of Sexual Behavior. 18 (1): 49–57. doi:10.1007/bf01579291. PMID 2540730. S2CID 22802329.
- ↑ Cunliffe WJ, Bottomley WW (September 1992). "Antiandrogens and acne. A topical approach?". Archives of Dermatology. 128 (9): 1261–4. doi:10.1001/archderm.1992.01680190117017. PMID 1387779.
- ↑ Vincenzi C, Trevisi P, Farina P, Stinchi C, Tosti A (November 1993). "Facial contact dermatitis due to spironolactone in an anti-acne cream". Contact Dermatitis. 29 (5): 277–8. doi:10.1111/j.1600-0536.1993.tb03569.x. PMID 8112074. S2CID 19134415.
- 1 2 Benvenga S (2009). "Therapy of Hirsutism". Diagnosis and Management of Polycystic Ovary Syndrome. pp. 233–242. doi:10.1007/978-0-387-09718-3_19. ISBN 978-0-387-09717-6.
- ↑ van Zuuren EJ, Fedorowicz Z, Carter B, Pandis N (April 2015). "Interventions for hirsutism (excluding laser and photoepilation therapy alone)". The Cochrane Database of Systematic Reviews. 2015 (4): CD010334. doi:10.1002/14651858.CD010334.pub2. PMC 6481758. PMID 25918921.
- ↑ Barrionuevo P, Nabhan M, Altayar O, Wang Z, Erwin PJ, Asi N, et al. (April 2018). "Treatment Options for Hirsutism: A Systematic Review and Network Meta-Analysis". The Journal of Clinical Endocrinology and Metabolism. 103 (4): 1258–1264. doi:10.1210/jc.2017-02052. PMID 29522176. S2CID 3783739.
- ↑ Erem C (2013). "Update on idiopathic hirsutism: diagnosis and treatment". Acta Clinica Belgica. 68 (4): 268–74. doi:10.2143/ACB.3267. PMID 24455796. S2CID 39120534.
- 1 2 Moretti C, Guccione L, Di Giacinto P, Simonelli I, Exacoustos C, Toscano V, et al. (March 2018). "Combined Oral Contraception and Bicalutamide in Polycystic Ovary Syndrome and Severe Hirsutism: A Double-Blind Randomized Controlled Trial". The Journal of Clinical Endocrinology and Metabolism. 103 (3): 824–838. doi:10.1210/jc.2017-01186. PMID 29211888. S2CID 3784055.
- 1 2 3 Kamangar F, Shinkai K (October 2012). "Acne in the adult female patient: a practical approach". International Journal of Dermatology. 51 (10): 1162–74. doi:10.1111/j.1365-4632.2012.05519.x. PMID 22994662. S2CID 5777817.
- 1 2 3 4 5 6 7 8 9 10 Diamanti-Kandarakis E (September 1999). "Current aspects of antiandrogen therapy in women". Current Pharmaceutical Design. 5 (9): 707–23. doi:10.2174/1381612805666230111201150. PMID 10495361.
- ↑ Shelley WB, Shelley ED (2001). Advanced Dermatologic Therapy II. W. B. Saunders. ISBN 978-0-7216-8258-7. Archived from the original on 6 October 2022. Retrieved 2 January 2019.
- ↑ Balen A, Franks S, Homburg R, Kehoe S (October 2010). Current Management of Polycystic Ovary Syndrome. Cambridge University Press. pp. 132–. ISBN 978-1-906985-41-7. Archived from the original on 6 October 2022. Retrieved 2 January 2019.
- ↑ Giorgetti R, di Muzio M, Giorgetti A, Girolami D, Borgia L, Tagliabracci A (March 2017). "Flutamide-induced hepatotoxicity: ethical and scientific issues". European Review for Medical and Pharmacological Sciences. 21 (1 Suppl): 69–77. PMID 28379593.
- ↑ Trivedi MK, Shinkai K, Murase JE (March 2017). "A Review of hormone-based therapies to treat adult acne vulgaris in women". International Journal of Women's Dermatology. 3 (1): 44–52. doi:10.1016/j.ijwd.2017.02.018. PMC 5419026. PMID 28492054.
- ↑ Yasa C, Dural Ö, Bastu E, Uğurlucan FG (2016). "Hirsutism, Acne, and Hair Loss: Management of Hyperandrogenic Cutaneous Manifestations of Polycystic Ovary Syndrome". Gynecology Obstetrics & Reproductive Medicine. 23 (2): 110–119. doi:10.21613/GORM.2016.613. ISSN 1300-4751.
- ↑ Barros B, Thiboutot D (2017). "Hormonal therapies for acne". Clinics in Dermatology. 35 (2): 168–172. doi:10.1016/j.clindermatol.2016.10.009. PMID 28274354.
- ↑ Hassoun LA, Chahal DS, Sivamani RK, Larsen LN (June 2016). "The use of hormonal agents in the treatment of acne". Seminars in Cutaneous Medicine and Surgery. 35 (2): 68–73. doi:10.12788/j.sder.2016.027. PMID 27416311.
- ↑ Azarchi S, Bienenfeld A, Lo Sicco K, Marchbein S, Shapiro J, Nagler AR (June 2019). "Androgens in women: Hormone-modulating therapies for skin disease". Journal of the American Academy of Dermatology. 80 (6): 1509–1521. doi:10.1016/j.jaad.2018.08.061. PMID 30312645. S2CID 52973096.
- ↑ van Zuuren EJ, Fedorowicz Z, Schoones J (May 2016). "Interventions for female pattern hair loss". The Cochrane Database of Systematic Reviews. 2016 (5): CD007628. doi:10.1002/14651858.CD007628.pub4. PMC 6457957. PMID 27225981.
- ↑ Brown J, Farquhar C, Lee O, Toomath R, Jepson RG (April 2009). "Spironolactone versus placebo or in combination with steroids for hirsutism and/or acne". The Cochrane Database of Systematic Reviews (2): CD000194. doi:10.1002/14651858.CD000194.pub2. PMID 19370553.
- 1 2 3 4 Hammerstein J (1990). "Antiandrogens: Clinical Aspects". Hair and Hair Diseases. pp. 827–886. doi:10.1007/978-3-642-74612-3_35. ISBN 978-3-642-74614-7.
- ↑ Muller NF, Dessing RP (19 June 1998). European Drug Index: European Drug Registrations (Fourth ed.). CRC Press. pp. 44–. ISBN 978-3-7692-2114-5. Archived from the original on 7 October 2022. Retrieved 29 November 2017.
- ↑ Lee M, Desai A (2007). Gibaldi's Drug Delivery Systems in Pharmaceutical Care. ASHP. pp. 312–. ISBN 978-1-58528-136-7. Archived from the original on 7 October 2022. Retrieved 1 December 2016.
- ↑ Niazi SK (19 April 2016). Handbook of Pharmaceutical Manufacturing Formulations, Second Edition: Volume One, Compressed Solid Products. CRC Press. pp. 470–. ISBN 978-1-4200-8117-6. Archived from the original on 7 October 2022. Retrieved 1 December 2016.
- 1 2 Wakelin SH, Maibach HI, Archer CB (1 June 2002). Systemic Drug Treatment in Dermatology: A Handbook. CRC Press. pp. 32, 35. ISBN 978-1-84076-013-2. Archived from the original on 7 October 2022. Retrieved 1 December 2016.
- 1 2 "Drugs@FDA: FDA Approved Drug Products". United States Food and Drug Administration. Archived from the original on 16 November 2016. Retrieved 14 August 2018.
- 1 2 3 4 5 6 7 8 Index Nominum 2000: International Drug Directory. Taylor & Francis. January 2000. pp. 960–. ISBN 978-3-88763-075-1.
- 1 2 3 4 5 6 7 8 9 "Spironolactone". Archived from the original on 2 December 2016. Retrieved 1 December 2016.
- 1 2 3 4 5 6 7 8 Kolkhof P, Bärfacker L (July 2017). "30 YEARS OF THE MINERALOCORTICOID RECEPTOR: Mineralocorticoid receptor antagonists: 60 years of research and development". The Journal of Endocrinology. 234 (1): T125–T140. doi:10.1530/JOE-16-0600. PMC 5488394. PMID 28634268.
- ↑ Goldsmith D, Covic A, Spaak J (12 November 2014). Cardio-Renal Clinical Challenges. Springer. pp. 167–. ISBN 978-3-319-09162-4. Archived from the original on 7 October 2022. Retrieved 17 August 2018.
- 1 2 3 4 5 6 7 8 9 10 11 Loriaux DL (November 1976). "Spironolactone and endocrine dysfunction". Annals of Internal Medicine. 85 (5): 630–6. doi:10.7326/0003-4819-85-5-630. PMID 984618.
- 1 2 3 4 5 6 7 8 9 Seldin DW, Giebisch GH (23 September 1997). Diuretic Agents: Clinical Physiology and Pharmacology. Academic Press. pp. 630–632. ISBN 978-0-08-053046-8. Archived from the original on 4 July 2014.
The incidence of spironolactone in men is dose related. It is estimated that 50% of men treated with ≥150 mg/day of spironolactone will develop gynecomastia. The degree of gynecomastia varies considerably from patient to patient but in most instances causes mild symptoms. Associated breast tenderness is common but an inconsistent feature.
- 1 2 3 4 5 6 7 8 9 10 11 Aronson JK (2 March 2009). Meyler's Side Effects of Cardiovascular Drugs. Elsevier. pp. 253–258. ISBN 978-0-08-093289-7. Archived from the original on 7 October 2022. Retrieved 16 October 2016.
Spironolactone causes breast tenderness and enlargement, mastodynia, infertility, cholasma, altered vaginal lubrica- tion, and reduced libido in women, probably because of estrogenic effects on target tissue.
- ↑ Carrell DT, Peterson CM (23 March 2010). Reproductive Endocrinology and Infertility: Integrating Modern Clinical and Laboratory Practice. Springer Science & Business Media. pp. 162–. ISBN 978-1-4419-1436-1. Archived from the original on 7 October 2022. Retrieved 6 October 2016.
A modest improvement in hirsutism can be anticipated in 70-80% of women using even the minimum of 100 mg of spironolactone per day for 6 months [157]. [...] The most common dosage is 100-200 mg per day in a divided dosage. Women treated with 200 mg/day show a greater reduction in hair shaft diameter than women receiving 100 mg/day [159]. [...] Menstrual irregularity (usually metrorrhagia), is the most common side effect of spironolactone and occurs in over 50% of patients with a dosage of 200 mg/day [159]. [...] Patients must be counseled to use contraception while taking spironolactone because it theoretically can feminize a male fetus.
- ↑ Pescovitz OH, Eugster EA (2004). Pediatric Endocrinology: Mechanisms, Manifestations, and Management. Lippincott Williams & Wilkins. pp. 368–. ISBN 978-0-7817-4059-3.
- ↑ Secora AM, Shin JI, Qiao Y, Alexander GC, Chang AR, Inker LA, et al. (November 2020). "Hyperkalemia and Acute Kidney Injury with Spironolactone Use Among Patients with Heart Failure". Mayo Clinic Proceedings. 95 (11): 2408–2419. doi:10.1016/j.mayocp.2020.03.035. PMC 8005315. PMID 33153631.
- ↑ "Spironolactone". MedlinePlus. U.S. National Library of Medicine. 2019. Archived from the original on 5 July 2016. Retrieved 31 October 2019.
- ↑ Verhamme K, Mosis G, Dieleman J, Stricker B, Sturkenboom M (August 2006). "Spironolactone and risk of upper gastrointestinal events: population based case-control study". BMJ. 333 (7563): 330. doi:10.1136/bmj.38883.479549.2F. PMC 1539051. PMID 16840442.
- ↑ Gulmez SE, Lassen AT, Aalykke C, Dall M, Andries A, Andersen BS, Hansen JM, Andersen M, Hallas J (August 2008). "Spironolactone use and the risk of upper gastrointestinal bleeding: a population-based case-control study". Br J Clin Pharmacol. 66 (2): 294–9. doi:10.1111/j.1365-2125.2008.03205.x. PMC 2492928. PMID 18507655.
- ↑ Wandelt-Freerksen E (July 1977). "[Aldactone in the treatment of sarcoidosis of the lungs (author's transl)]". Zeitschrift für Erkrankungen der Atmungsorgane. 149 (1): 156–9. PMID 607621.
- 1 2 Lainscak M, Pelliccia F, Rosano G, Vitale C, Schiariti M, Greco C, et al. (December 2015). "Safety profile of mineralocorticoid receptor antagonists: Spironolactone and eplerenone". International Journal of Cardiology. 200: 25–9. doi:10.1016/j.ijcard.2015.05.127. PMID 26404748.
- ↑ Juurlink DN, Mamdani MM, Lee DS, Kopp A, Austin PC, Laupacis A, Redelmeier DA (August 2004). "Rates of hyperkalemia after publication of the Randomized Aldactone Evaluation Study". The New England Journal of Medicine. 351 (6): 543–51. doi:10.1056/NEJMoa040135. PMID 15295047.
- ↑ Zannad F, Gattis Stough W, Rossignol P, Bauersachs J, McMurray JJ, Swedberg K, et al. (November 2012). "Mineralocorticoid receptor antagonists for heart failure with reduced ejection fraction: integrating evidence into clinical practice". European Heart Journal. 33 (22): 2782–95. doi:10.1093/eurheartj/ehs257. PMID 22942339.
- ↑ Wei L, Struthers AD, Fahey T, Watson AD, Macdonald TM (May 2010). "Spironolactone use and renal toxicity: population based longitudinal analysis". BMJ. 340: c1768. doi:10.1136/bmj.c1768. PMID 20483947. S2CID 14815504.
- ↑ Antoniou T, Gomes T, Mamdani MM, Yao Z, Hellings C, Garg AX, Weir MA, Juurlink DN (September 2011). "Trimethoprim-sulfamethoxazole induced hyperkalaemia in elderly patients receiving spironolactone: nested case-control study". BMJ. 343: d5228. doi:10.1136/bmj.d5228. PMC 3171211. PMID 21911446.
- ↑ Antoniou T, Hollands S, Macdonald EM, Gomes T, Mamdani MM, Juurlink DN (March 2015). "Trimethoprim-sulfamethoxazole and risk of sudden death among patients taking spironolactone". CMAJ. 187 (4): E138–E143. doi:10.1503/cmaj.140816. PMC 4347789. PMID 25646289.
- 1 2 3 Plovanich M, Weng QY, Mostaghimi A (September 2015). "Low Usefulness of Potassium Monitoring Among Healthy Young Women Taking Spironolactone for Acne". JAMA Dermatology. 151 (9): 941–4. doi:10.1001/jamadermatol.2015.34. PMID 25796182.
- 1 2 3 Becker KL (2001). Principles and Practice of Endocrinology and Metabolism. Lippincott Williams & Wilkins. pp. 708, 777, 1087, 1196. ISBN 978-0-7817-1750-2. Archived from the original on 6 October 2022. Retrieved 6 May 2018.
Spironolactone has been used successfully in dosages of 100 to 200 mg daily for the treatment of idiopathic hirsutism and hirsutism associated with polycystic ovarian disease (see Chaps. 96 and 101).184 [...] Spironolactone also is both an antiandrogen and a progestagen, and this explains many of its distressing side effects; decreased libido, mastodynia, and gynecomastia may occur in 50% or more of men, and menometrorrhagia and breast pain may occur in an equally large number of women taking the drug.27
- 1 2 3 Tsioufis C, Schmieder R, Mancia G (15 August 2016). Interventional Therapies for Secondary and Essential Hypertension. Springer. p. 44. ISBN 978-3-319-34141-5. Archived from the original on 7 October 2022. Retrieved 16 October 2016.
Gynecomastia is dose related and reaches almost 50% with high spironolactone doses (>150 mg daily), while it is much less common (5–10%) with low doses (25–50 mg spironolactone daily) [135].
- ↑ Conn JJ, Jacobs HS (July 1998). "Managing hirsutism in gynaecological practice". British Journal of Obstetrics and Gynaecology. 105 (7): 687–96. doi:10.1111/j.1471-0528.1998.tb10197.x. PMID 9692407. S2CID 34751086.
Breast tenderness is not uncommon and is recorded in up to 40% of women taking higher doses63.
- 1 2 Side Effects of Drugs Annual: A worldwide yearly survey of new data in adverse drug reactions. Elsevier Science. 1 December 2014. p. 293. ISBN 978-0-444-63391-0.
It is well known that gynecomastia is a side effect of spironolactone in men and occurs in a dose-dependent manner in ~7% of cases with doses of <50 mg per day, and up to 50% of cases with doses of >150 mg per day [40,41].
- 1 2 3 McInnes GT (2008). Clinical Pharmacology and Therapeutics of Hypertension. Elsevier. p. 125. ISBN 978-0-444-51757-9. Archived from the original on 7 October 2022. Retrieved 6 October 2016.
Spironolactone lacks specificty for mineralocorticoid receptors and binds to both progesterone and dihydrotestosterone receptors. This can lead to various endocrine side effects that can limit the use of spironolactone. In females spironolactone can induce menstrual disturbances, breast enlargement and breast tenderness.78 In men spironolactone can induce gynecomastia and impotence. In RALES gynaecomastia or breast pain was reported by 10% of the men in the spironolactone group and 1% of the men in the placebo group (p<0.001), causing more patients in the spironolactone group than in the placebo group to discontinue treatment, despite a mean spironolactone dose of 26 mg.18
- 1 2 3 4 5 Ménard J (March 2004). "The 45-year story of the development of an anti-aldosterone more specific than spironolactone". Molecular and Cellular Endocrinology. 217 (1–2): 45–52. doi:10.1016/j.mce.2003.10.008. PMID 15134800. S2CID 19701784.
[Spironolactone] was synthesized after the demonstration of the natriuretic effect of progesterone (Landau et al., 1955).
- 1 2 3 4 5 6 7 Thompson DF, Carter JR (1993). "Drug-induced gynecomastia". Pharmacotherapy. 13 (1): 37–45. doi:10.1002/j.1875-9114.1993.tb02688.x. PMID 8094898. S2CID 30322620.
- 1 2 Wilcox CS (22 August 2008). Therapy in Nephrology and Hypertension E-Book: A Companion to Brenner & Rector's The Kidney. Elsevier Health Sciences. pp. 607–. ISBN 978-1-4377-1124-0. Archived from the original on 7 October 2022. Retrieved 17 August 2018.
- ↑ Eckman A, Dobs A (November 2008). "Drug-induced gynecomastia". Expert Opinion on Drug Safety. 7 (6): 691–702. doi:10.1517/14740330802442382. PMID 18983216. S2CID 72716346.
- ↑ Mathur R, Braunstein GD (1997). "Gynecomastia: pathomechanisms and treatment strategies". Hormone Research. 48 (3): 95–102. doi:10.1159/000185497. PMID 11546925.
- ↑ Christy NA, Franks AS, Cross LB (September 2005). "Spironolactone for hirsutism in polycystic ovary syndrome". The Annals of Pharmacotherapy. 39 (9): 1517–21. doi:10.1345/aph.1G025. PMID 16076921. S2CID 45708497.
- ↑ Spritzer PM, Lisboa KO, Mattiello S, Lhullier F (May 2000). "Spironolactone as a single agent for long-term therapy of hirsute patients". Clinical Endocrinology. 52 (5): 587–94. doi:10.1046/j.1365-2265.2000.00982.x. PMID 10792338. S2CID 40606594.
- ↑ Rabe T, Grunwald K, Feldmann K, Runnebaum B (2009). "Treatment of hyperandrogenism in women". Gynecological Endocrinology. 10 (sup3): 1–44. doi:10.3109/09513599609045658. ISSN 0951-3590.
- 1 2 3 4 5 6 7 8 9 10 McMullen GR, Van Herle AJ (December 1993). "Hirsutism and the effectiveness of spironolactone in its management". Journal of Endocrinological Investigation. 16 (11): 925–32. doi:10.1007/BF03348960. PMID 8144871. S2CID 42231952.
- ↑ Nakajima ST, Brumsted JR, Riddick DH, Gibson M (July 1989). "Absence of progestational activity of oral spironolactone". Fertility and Sterility. 52 (1): 155–8. doi:10.1016/s0015-0282(16)60807-5. PMID 2744183.
- ↑ Olsson HL, Olsson ML (2020). "The Menstrual Cycle and Risk of Breast Cancer: A Review". Frontiers in Oncology. 10: 21. doi:10.3389/fonc.2020.00021. PMC 6993118. PMID 32038990.
- ↑ Jemec G, Revuz J, Leyden JJ (24 November 2006). Hidradenitis Suppurativa. Springer Science & Business Media. pp. 125–. ISBN 978-3-540-33101-8. Archived from the original on 7 October 2022. Retrieved 15 August 2018.
- 1 2 ter Heegde F, De Rijk RH, Vinkers CH (February 2015). "The brain mineralocorticoid receptor and stress resilience". Psychoneuroendocrinology. 52: 92–110. doi:10.1016/j.psyneuen.2014.10.022. hdl:1874/331554. PMID 25459896. S2CID 14297156.
- 1 2 Schultebraucks K (2016). The Role of the Mineralocorticoid Receptor for Cognitive Function, Mood and Social Cognition (PDF) (Dissertation). doi:10.17169/refubium-6940. Archived from the original on 28 December 2018. Retrieved 27 December 2018.
[...] Taken together, there is evidence that the MR influences mood in healthy participants and patients with psychiatric disorders. However, due to the heterogeneous findings, it still remains unclear whether MR stimulation (e.g. fludrocortisone) or rather MR blockage (e.g. spironolactone) leads to better mood.
- 1 2 Holsboer F (1999). "The rationale for corticotropin-releasing hormone receptor (CRH-R) antagonists to treat depression and anxiety". Journal of Psychiatric Research. 33 (3): 181–214. doi:10.1016/S0022-3956(98)90056-5. PMID 10367986.
- ↑ Basson R, Prior JC (1998). "Hormonal Therapy of Gender Dysphoria: The Male-to-Female Transsexual". In Denny D (ed.). Current Concepts in Transgender Identity. Taylor & Francis. pp. 277–296. doi:10.4324/9780203775134. ISBN 978-1-134-82110-5. Archived from the original on 7 October 2022. Retrieved 2 January 2019.
- 1 2 3 Baldani DP, Skrgatic L, Ougouag R, Kasum M (February 2018). "The cardiometabolic effect of current management of polycystic ovary syndrome: strategies of prevention and treatment". Gynecol Endocrinol. 34 (2): 87–91. doi:10.1080/09513590.2017.1381681. PMID 28944709. S2CID 205631980.
- 1 2 3 Nakhjavani M, Hamidi S, Esteghamati A, Abbasi M, Nosratian-Jahromi S, Pasalar P (October 2009). "Short term effects of spironolactone on blood lipid profile: a 3-month study on a cohort of young women with hirsutism". Br J Clin Pharmacol. 68 (4): 634–7. doi:10.1111/j.1365-2125.2009.03483.x. PMC 2780289. PMID 19843067.
- ↑ Grundy SM, Stone NJ, Bailey AL, Beam C, Birtcher KK, Blumenthal RS, Braun LT, de Ferranti S, Faiella-Tommasino J, Forman DE, Goldberg R, Heidenreich PA, Hlatky MA, Jones DW, Lloyd-Jones D, Lopez-Pajares N, Ndumele CE, Orringer CE, Peralta CA, Saseen JJ, Smith SC, Sperling L, Virani SS, Yeboah J (June 2019). "2018 AHA/ACC/AACVPR/AAPA/ABC/ACPM/ADA/AGS/APhA/ASPC/NLA/PCNA Guideline on the Management of Blood Cholesterol: A Report of the American College of Cardiology/American Heart Association Task Force on Clinical Practice Guidelines". Circulation. 139 (25): e1082–e1143. doi:10.1161/CIR.0000000000000625. PMC 7403606. PMID 30586774.
- ↑ Coleman E, Radix AE, Bouman WP, Brown GR, de Vries AL, Deutsch MB, et al. (19 August 2022). "Standards of Care for the Health of Transgender and Gender Diverse People, Version 8". International Journal of Transgender Health. 23 (Suppl 1): S1–S259. doi:10.1080/26895269.2022.2100644. ISSN 2689-5269. PMC 9553112. PMID 36238954.
- ↑ Godsland IF, Wynn V, Crook D, Miller NE (December 1987). "Sex, plasma lipoproteins, and atherosclerosis: prevailing assumptions and outstanding questions". American Heart Journal. 114 (6): 1467–1503. doi:10.1016/0002-8703(87)90552-7. PMID 3318361.
- ↑ Cignarella A, Mioni R, Sabbadin C, Dassie F, Parolin M, Vettor R, Barbot M, Scaroni C (December 2020). "Pharmacological Approaches to Controlling Cardiometabolic Risk in Women with PCOS". Int J Mol Sci. 21 (24): 9554. doi:10.3390/ijms21249554. PMC 7765466. PMID 33334002.
- ↑ Lopes RJ, Lourenço AP, Mascarenhas J, Azevedo A, Bettencourt P (November 2008). "Safety of spironolactone use in ambulatory heart failure patients". Clinical Cardiology. 31 (11): 509–13. doi:10.1002/clc.20284. PMC 6652974. PMID 19006114.
- ↑ Thai KE, Sinclair RD (August 2001). "Spironolactone-induced hepatitis". The Australasian Journal of Dermatology. 42 (3): 180–2. doi:10.1046/j.1440-0960.2001.00510.x. PMID 11488711. S2CID 12160891.
- ↑ "Aldactazide (spironolactone/hydrochlorothiazide) Tablets". Food and Drug Administration. Archived from the original on 10 March 2015. Retrieved 3 March 2014.
- ↑ online.lexi.com/lco/action/doc/retrieve/docid/patch_f/7699#f_adverse-reactions
- ↑ Aiba M, Suzuki H, Kageyama K, Murai M, Tazaki H, Abe O, Saruta T (June 1981). "Spironolactone bodies in aldosteronomas and in the attached adrenals. Enzyme histochemical study of 19 cases of primary aldosteronism and a case of aldosteronism due to bilateral diffuse hyperplasia of the zona glomerulosa". The American Journal of Pathology. 103 (3): 404–10. PMC 1903848. PMID 7195152.
- 1 2 Ainsworth SB (10 November 2014). Neonatal Formulary: Drug Use in Pregnancy and the First Year of Life. John Wiley & Sons. pp. 486–. ISBN 978-1-118-81959-3. Archived from the original on 8 September 2017.
- 1 2 3 4 5 6 Little B (29 September 2006). Drugs and Pregnancy: A Handbook. CRC Press. pp. 63–. ISBN 978-0-340-80917-4. Archived from the original on 8 September 2017.
- 1 2 3 Rubin PC, Ramsey M (30 April 2008). Prescribing in Pregnancy. John Wiley & Sons. pp. 83–. ISBN 978-0-470-69555-5. Archived from the original on 8 September 2017.
- 1 2 3 Briggs GG, Freeman RK, Yaffe SJ (2011). Drugs in Pregnancy and Lactation: A Reference Guide to Fetal and Neonatal Risk. Lippincott Williams & Wilkins. pp. 1349–. ISBN 978-1-60831-708-0. Archived from the original on 8 September 2017.
- ↑ Gleicher N, Elkayam U, Gleicher N (23 June 1998). Cardiac Problems in Pregnancy: Diagnosis and Management of Maternal and Fetal Heart Disease. John Wiley & Sons. pp. 353–. ISBN 978-0-471-16358-9. Archived from the original on 8 September 2017.
- 1 2 3 4 Schaefer C (2001). Drugs During Pregnancy and Lactation: Handbook of Prescription Drugs and Comparative Risk Assessment. Gulf Professional Publishing. pp. 115, 143. ISBN 978-0-444-50763-1. Archived from the original on 8 September 2017.
- ↑ Upfal J (2006). Australian Drug Guide. Black Inc. pp. 671–. ISBN 978-1-86395-174-6. Archived from the original on 8 September 2017.
- 1 2 Liszewski W, Boull C (April 2019). "Lack of evidence for feminization of males exposed to spironolactone in utero: A systematic review". Journal of the American Academy of Dermatology. 80 (4): 1147–1148. doi:10.1016/j.jaad.2018.10.023. PMID 30352280. S2CID 53022388.
- ↑ Garthwaite SM, McMahon EG (March 2004). "The evolution of aldosterone antagonists". Molecular and Cellular Endocrinology. 217 (1–2): 27–31. doi:10.1016/j.mce.2003.10.005. PMID 15134797. S2CID 8499861.
- ↑ "Advisory Statement" (PDF). Klinge Chemicals / LoSalt. Archived from the original (PDF) on 15 November 2006. Retrieved 15 March 2007.
- ↑ Juvet T, Gourineni VC, Ravi S, Zarich SW (September 2013). "Life-threatening hyperkalemia: a potentially lethal drug combination". Connecticut Medicine. 77 (8): 491–3. PMID 24156179.
- ↑ Davis MP (28 May 2009). Opioids in Cancer Pain. OUP Oxford. pp. 222–. ISBN 978-0-19-923664-0. Archived from the original on 7 October 2022. Retrieved 6 October 2016.
- 1 2 3 4 5 Shaw JC (February 1991). "Spironolactone in dermatologic therapy". Journal of the American Academy of Dermatology. 24 (2 Pt 1): 236–43. doi:10.1016/0190-9622(91)70034-Y. PMID 1826112.
- ↑ Wolverton SE (8 March 2007). Comprehensive Dermatologic Drug Therapy. Elsevier Health Sciences. pp. 2677–. ISBN 978-1-4377-2070-9. Archived from the original on 7 October 2022. Retrieved 7 May 2017.
- 1 2 Leinung MC, Feustel PJ, Joseph J (2018). "Hormonal Treatment of Transgender Women with Oral Estradiol". Transgender Health. 3 (1): 74–81. doi:10.1089/trgh.2017.0035. PMC 5944393. PMID 29756046.
- ↑ Jhajra S, Ramesh Varkhede N, Suresh Ahire D, Vidyasagar Naik B, Prasad B, Paliwal J, Singh S (2012). "Extrahepatic Drug-Metabolizing Enzymes and Their Significance". Encyclopedia of Drug Metabolism and Interactions. pp. 1–99. doi:10.1002/9780470921920.edm028. ISBN 978-0-470-92192-0.
- 1 2 3 Armanini D, Andrisani A, Bordin L, Sabbadin C (September 2016). "Spironolactone in the treatment of polycystic ovary syndrome". Expert Opinion on Pharmacotherapy. 17 (13): 1713–5. doi:10.1080/14656566.2016.1215430. PMID 27450358. S2CID 19345088.
- 1 2 Armanini D, Castello R, Scaroni C, Bonanni G, Faccini G, Pellati D, et al. (March 2007). "Treatment of polycystic ovary syndrome with spironolactone plus licorice". European Journal of Obstetrics, Gynecology, and Reproductive Biology. 131 (1): 61–67. doi:10.1016/j.ejogrb.2006.10.013. PMID 17113210.
- ↑ Salassa RM, Mattox VR, Rosevear JW (November 1962). "Inhibition of the "mineralocorticoid" activity of licorice by spironolactone". The Journal of Clinical Endocrinology and Metabolism. 22 (11): 1156–9. doi:10.1210/jcem-22-11-1156. PMID 13991036.
- ↑ Omar HR, Komarova I, El-Ghonemi M, Fathy A, Rashad R, Abdelmalak HD, et al. (August 2012). "Licorice abuse: time to send a warning message". Therapeutic Advances in Endocrinology and Metabolism. 3 (4): 125–38. doi:10.1177/2042018812454322. PMC 3498851. PMID 23185686.
- ↑ Lin SH, Yang SS, Chau T, Halperin ML (March 2003). "An unusual cause of hypokalemic paralysis: chronic licorice ingestion". The American Journal of the Medical Sciences. 325 (3): 153–6. doi:10.1097/00000441-200303000-00008. PMID 12640291.
- ↑ Parthasarathy HK, MacDonald TM (March 2007). "Mineralocorticoid receptor antagonists". Current Hypertension Reports. 9 (1): 45–52. doi:10.1007/s11906-007-0009-3. PMID 17362671. S2CID 2090391.
- ↑ Holsboer, F. The Rationale for Corticotropin-Releasing Hormone Receptor (CRH-R) Antagonists to Treat Depression and Anxiety. J. Psychiatr. Res. 33, 181–214 (1999).
- ↑ Otte C, Hinkelmann K, Moritz S, Yassouridis A, Jahn H, Wiedemann K, Kellner M (April 2010). "Modulation of the mineralocorticoid receptor as add-on treatment in depression: a randomized, double-blind, placebo-controlled proof-of-concept study". Journal of Psychiatric Research. 44 (6): 339–46. doi:10.1016/j.jpsychires.2009.10.006. PMID 19909979.
- ↑ Mostalac-Preciado CR, de Gortari P, López-Rubalcava C (September 2011). "Antidepressant-like effects of mineralocorticoid but not glucocorticoid antagonists in the lateral septum: interactions with the serotonergic system". Behavioural Brain Research. 223 (1): 88–98. doi:10.1016/j.bbr.2011.04.008. PMID 21515309. S2CID 26986501.
- 1 2 3 Agusti G, Bourgeois S, Cartiser N, Fessi H, Le Borgne M, Lomberget T (January 2013). "A safe and practical method for the preparation of 7α-thioether and thioester derivatives of spironolactone". Steroids. 78 (1): 102–7. doi:10.1016/j.steroids.2012.09.005. PMID 23063964. S2CID 8992318.
- 1 2 3 International Agency for Research on Cancer; World Health Organization (2001). Some Thyrotropic Agents. World Health Organization. pp. 325–. ISBN 978-92-832-1279-9. Archived from the original on 7 October 2022. Retrieved 6 October 2016.
- ↑ Ginés P, Arroyo V, Rodés J, Schrier RW (15 April 2008). Ascites and Renal Dysfunction in Liver Disease: Pathogenesis, Diagnosis, and Treatment. John Wiley & Sons. pp. 229, 231. ISBN 978-1-4051-4370-7. Archived from the original on 7 October 2022. Retrieved 6 May 2018.
The most rational treatment of cirrhotic patients with ascites appears to be the administration of an aldosterone antagonist. A stepwise equential therapy with increasing oral doses of an aldosterone antagonist (up to 400 mg/day) may be effective in mobilizing ascites in 60-80% of non-azotemic cirrhotic patients with ascites who do not respond to bed rest and dietary sodium restriction (11,12,74). The effective dosage of aldosterone antagonists depends on plasma aldosterone levels (75). Patients with moderately increased plasma levels require low doses of those drugs (100-150 mg/day), whereas patients with marked hyperaldosteronism may require as much as 200-400 mg/day. A further increase of the dosage up to 500-600 mg/day is of limited usefulness (11,12).
- ↑ Feldman AM (15 April 2008). Heart Failure: Pharmacologic Management. John Wiley & Sons. pp. 89–103. ISBN 978-1-4051-7253-0. Archived from the original on 7 October 2022. Retrieved 13 August 2018.
- ↑ Walar K (15 June 2015). Pharmacology (6th ed.). Wolter Kluwer Health. pp. 248–249. GGKEY:N57K51AQ0UA.
- ↑ Tamargo J, Segura J, Ruilope LM (April 2014). "Diuretics in the treatment of hypertension. Part 2: loop diuretics and potassium-sparing agents". Expert Opinion on Pharmacotherapy. 15 (5): 605–21. doi:10.1517/14656566.2014.879117. PMID 24456327. S2CID 2338377.
- 1 2 3 Doggrell SA, Brown L (May 2001). "The spironolactone renaissance". Expert Opinion on Investigational Drugs. 10 (5): 943–54. doi:10.1517/13543784.10.5.943. PMID 11322868. S2CID 39820875.
- ↑ Strauss III JF, Barbieri RL (13 September 2013). Yen and Jaffe's Reproductive Endocrinology. Elsevier Health Sciences. pp. 237–. ISBN 978-1-4557-2758-2. Archived from the original on 7 October 2022. Retrieved 13 August 2018.
- ↑ Tremblay RR (May 1986). "Treatment of hirsutism with spironolactone". Clinics in Endocrinology and Metabolism. 15 (2): 363–71. doi:10.1016/S0300-595X(86)80030-5. PMID 2941190.
- ↑ Haff GG, Triplett NT (23 September 2015). Essentials of Strength Training and Conditioning 4th Edition. Human Kinetics. pp. 76–. ISBN 978-1-4925-0162-6. Archived from the original on 7 October 2022. Retrieved 14 August 2018.
- 1 2 Wu JJ (18 October 2012). Comprehensive Dermatologic Drug Therapy E-Book. Elsevier Health Sciences. pp. 364–. ISBN 978-1-4557-3801-4. Archived from the original on 7 October 2022. Retrieved 6 May 2018.
Spironolactone is an aldosterone antagonist and a relatively weak antiandrogen that blocks the AR and inhibits androgen biosynthesis. Spironolactone does not inhibit 5α-reductase. [...] The progestational activity of spironolactone is variable. The drug influences the ratio of luteinizing hormone (LH) to follicle-stimulating hormone (FSH) by reducing the response of LH to GnRH. [...] In a dose range of 25-200 mg a linear relationship between a single dose of spironolactone and plasma levels of canrenone occurs within 96 hours. [...] Common doses [of spironolactone for dermatological indications] range between 50 and 200 mg daily, with 100 mg daily typically being better tolerated than higher dosages.20
- ↑ Coelingh Benni HJ, Vemer HM (15 December 1990). Chronic Hyperandrogenic Anovulation. CRC Press. pp. 152–. ISBN 978-1-85070-322-8. Archived from the original on 7 October 2022. Retrieved 6 October 2016.
- ↑ Shaw JC (November 1996). "Antiandrogen therapy in dermatology". International Journal of Dermatology. 35 (11): 770–8. doi:10.1111/j.1365-4362.1996.tb02970.x. PMID 8915726. S2CID 39334280.
- 1 2 3 Colby HD (April 1981). "Chemical suppression of steroidogenesis". Environmental Health Perspectives. 38: 119–27. doi:10.1289/ehp.8138119. PMC 1568425. PMID 6786868.
- ↑ Rocca ML, Venturella R, Mocciaro R, Di Cello A, Sacchinelli A, Russo V, et al. (June 2015). "Polycystic ovary syndrome: chemical pharmacotherapy". Expert Opinion on Pharmacotherapy. 16 (9): 1369–93. doi:10.1517/14656566.2015.1047344. PMID 26001184. S2CID 43770017.
- ↑ Ye P, Yamashita T, Pollock DM, Sasano H, Rainey WE (January 2009). "Contrasting effects of eplerenone and spironolactone on adrenal cell steroidogenesis". Hormone and Metabolic Research. 41 (1): 35–9. doi:10.1055/s-0028-1087188. PMC 4277847. PMID 18819053.
- ↑ Watts S, Faingold C, Dunaway G, Crespo L (1 April 2009). Brody's Human Pharmacology - E-Book. Elsevier Health Sciences. pp. 472–. ISBN 978-0-323-07575-6.
- 1 2 Satoh T, Itoh S, Seki T, Itoh S, Nomura N, Yoshizawa I (October 2002). "On the inhibitory action of 29 drugs having side effect gynecomastia on estrogen production". The Journal of Steroid Biochemistry and Molecular Biology. 82 (2–3): 209–16. doi:10.1016/S0960-0760(02)00154-1. PMID 12477487. S2CID 9972497.
- ↑ Rose LI, Underwood RH, Newmark SR, Kisch ES, Williams GH (October 1977). "Pathophysiology of spironolactone-induced gynecomastia". Annals of Internal Medicine. 87 (4): 398–403. doi:10.7326/0003-4819-87-4-398. PMID 907238.
- ↑ Poirier D (March 2003). "Inhibitors of 17 beta-hydroxysteroid dehydrogenases". Current Medicinal Chemistry. 10 (6): 453–77. doi:10.2174/0929867033368222. PMID 12570693.
- ↑ Poirier D (July 2009). "Advances in development of inhibitors of 17beta hydroxysteroid dehydrogenases". Anti-Cancer Agents in Medicinal Chemistry. 9 (6): 642–60. doi:10.2174/187152009788680000. PMID 19601747.
- ↑ Biggar RJ, Andersen EW, Wohlfahrt J, Melbye M (December 2013). "Spironolactone use and the risk of breast and gynecologic cancers". Cancer Epidemiology. 37 (6): 870–5. doi:10.1016/j.canep.2013.10.004. PMID 24189467.
- ↑ Soubhye J, Alard IC, van Antwerpen P, Dufrasne F (2015). "Type 2 17-β hydroxysteroid dehydrogenase as a novel target for the treatment of osteoporosis". Future Medicinal Chemistry. 7 (11): 1431–56. doi:10.4155/fmc.15.74. PMID 26230882.
- ↑ Adams KF (28 October 2014). Pharmacologic Approaches to Heart Failure, An Issue of Heart Failure Clinics, E-Book. Elsevier Health Sciences. pp. 562–. ISBN 978-0-323-32612-4. Archived from the original on 7 October 2022. Retrieved 13 August 2018.
- 1 2 Berardelli R, Karamouzis I, D'Angelo V, Zichi C, Fussotto B, Giordano R, et al. (February 2013). "Role of mineralocorticoid receptors on the hypothalamus-pituitary-adrenal axis in humans". Endocrine. 43 (1): 51–8. doi:10.1007/s12020-012-9750-8. PMID 22836869. S2CID 34916537.
- 1 2 Otte C, Moritz S, Yassouridis A, Koop M, Madrischewski AM, Wiedemann K, Kellner M (January 2007). "Blockade of the mineralocorticoid receptor in healthy men: effects on experimentally induced panic symptoms, stress hormones, and cognition". Neuropsychopharmacology. 32 (1): 232–8. doi:10.1038/sj.npp.1301217. PMID 17035932. S2CID 10624783.
- ↑ Hinkelmann K, Hellmann-Regen J, Wingenfeld K, Kuehl LK, Mews M, Fleischer J, et al. (November 2016). "Mineralocorticoid receptor function in depressed patients and healthy individuals". Progress in Neuro-Psychopharmacology & Biological Psychiatry. 71: 183–8. doi:10.1016/j.pnpbp.2016.08.003. PMID 27519144. S2CID 4775178.
- ↑ Falcone T, Hurd WW (1 January 2007). Clinical Reproductive Medicine and Surgery. Elsevier Health Sciences. pp. 271–. ISBN 978-0-323-03309-1. Archived from the original on 7 October 2022. Retrieved 13 August 2018.
- ↑ Abshagen U, Spörl S, L'age M (February 1978). "Non-interaction of spironolactone medication and cortisol metabolism in man". Klinische Wochenschrift. 56 (3): 135–8. doi:10.1007/BF01478568. PMID 628197. S2CID 30885047.
- ↑ Yamaji M, Tsutamoto T, Kawahara C, Nishiyama K, Yamamoto T, Fujii M, Horie M (November 2010). "Effect of eplerenone versus spironolactone on cortisol and hemoglobin A1(c) levels in patients with chronic heart failure". American Heart Journal. 160 (5): 915–21. doi:10.1016/j.ahj.2010.04.024. PMID 21095280.
- ↑ Kuntz E, Kuntz HD (11 March 2009). Hepatology: Textbook and Atlas. Springer Science & Business Media. pp. 312–. ISBN 978-3-540-76839-5. Archived from the original on 7 October 2022. Retrieved 13 August 2018.
- ↑ Melmed S, Polonsky KS, Larsen PR, Kronenberg HM (12 May 2011). Williams Textbook of Endocrinology E-Book. Elsevier Health Sciences. pp. 571–. ISBN 978-1-4377-3600-7.
- ↑ Kliewer SA, Goodwin B, Willson TM (October 2002). "The nuclear pregnane X receptor: a key regulator of xenobiotic metabolism". Endocrine Reviews. 23 (5): 687–702. doi:10.1210/er.2001-0038. PMID 12372848.
- ↑ Sabbadin C, Andrisani A, Zermiani M, Donà G, Bordin L, Ragazzi E, et al. (September 2016). "Spironolactone and intermenstrual bleeding in polycystic ovary syndrome with normal BMI". Journal of Endocrinological Investigation. 39 (9): 1015–21. doi:10.1007/s40618-016-0466-0. PMID 27072668. S2CID 34201900.
- ↑ Delyani JA (April 2000). "Mineralocorticoid receptor antagonists: the evolution of utility and pharmacology". Kidney International. 57 (4): 1408–11. doi:10.1046/j.1523-1755.2000.00983.x. PMID 10760075.
- ↑ Lehmann JM, McKee DD, Watson MA, Willson TM, Moore JT, Kliewer SA (September 1998). "The human orphan nuclear receptor PXR is activated by compounds that regulate CYP3A4 gene expression and cause drug interactions". The Journal of Clinical Investigation. 102 (5): 1016–23. doi:10.1172/JCI3703. PMC 508967. PMID 9727070.
- ↑ Karim A (1978). "Spironolactone: disposition, metabolism, pharmacodynamics, and bioavailability". Drug Metabolism Reviews. 8 (1): 151–88. doi:10.3109/03602537808993782. PMID 363379.
- ↑ Beermann B (1984). "Aspects on pharmacokinetics of some diuretics". Acta Pharmacologica et Toxicologica. 54 (Suppl 1): 17–29. doi:10.1111/j.1600-0773.1984.tb03626.x. PMID 6369882.
- ↑ Overdiek HW, Merkus FW (1987). "The metabolism and biopharmaceutics of spironolactone in man". Reviews on Drug Metabolism and Drug Interactions. 5 (4): 273–302. doi:10.1515/DMDI.1987.5.4.273. PMID 3333882. S2CID 29482256.
- ↑ Brater DC (November 2011). "Update in diuretic therapy: clinical pharmacology". Seminars in Nephrology. 31 (6): 483–94. doi:10.1016/j.semnephrol.2011.09.003. PMID 22099505.
- ↑ Kolkhof P, Borden SA (March 2012). "Molecular pharmacology of the mineralocorticoid receptor: prospects for novel therapeutics". Molecular and Cellular Endocrinology. 350 (2): 310–7. doi:10.1016/j.mce.2011.06.025. PMID 21771637. S2CID 36894459.
- ↑ Yang J, Young MJ (April 2016). "Mineralocorticoid receptor antagonists-pharmacodynamics and pharmacokinetic differences". Current Opinion in Pharmacology. 27: 78–85. doi:10.1016/j.coph.2016.02.005. PMID 26939027.
- ↑ Kolkhof P, Jaisser F, Kim SY, Filippatos G, Nowack C, Pitt B (2017). "Steroidal and Novel Non-steroidal Mineralocorticoid Receptor Antagonists in Heart Failure and Cardiorenal Diseases: Comparison at Bench and Bedside". Heart Failure. Handbook of Experimental Pharmacology. Vol. 243. pp. 271–305. doi:10.1007/164_2016_76. ISBN 978-3-319-59658-7. PMID 27830348.
- ↑ Jankowski A, Skorek-Jankowska A, Lamparczyk H (June 1996). "Simultaneous determination of spironolactone and its metabolites in human plasma". Journal of Pharmaceutical and Biomedical Analysis. 14 (8–10): 1359–65. doi:10.1016/S0731-7085(96)01767-0. PMID 8818057.
- 1 2 Deinum J, Riksen NP, Lenders JW (October 2015). "Pharmacological treatment of aldosterone excess". Pharmacology & Therapeutics. 154: 120–33. doi:10.1016/j.pharmthera.2015.07.006. PMID 26213109.
- ↑ Overdiek HW, Merkus FW (November 1986). "Influence of food on the bioavailability of spironolactone". Clinical Pharmacology and Therapeutics. 40 (5): 531–6. doi:10.1038/clpt.1986.219. PMID 3769384. S2CID 32313529.
- ↑ Melander A, Danielson K, Scherstén B, Thulin T, Wåhlin E (July 1977). "Enhancement by food of canrenone bioavailability from spironolactone". Clinical Pharmacology and Therapeutics. 22 (1): 100–3. doi:10.1002/cpt1977221100. PMID 872489. S2CID 12827850.
- ↑ Saini-Chohan HK, Hatch GM (March 2009). "Biological actions and metabolism of currently used pharmacological agents for the treatment of congestive heart failure". Current Drug Metabolism. 10 (3): 206–19. doi:10.2174/138920009787846314. PMID 19442083.
- ↑ Al-Hadiya BM, Belal F, Asiri YA, Gubara OA (2002). "Spironolactone". Analytical Profiles of Drug Substances and Excipients. 29: 261–320. doi:10.1016/S1075-6280(02)29009-6. ISBN 978-0-12-260829-2. ISSN 1075-6280.
- 1 2 Aldosterone. Elsevier Science. 23 January 2019. pp. 11, 46. ISBN 978-0-12-817783-9. Archived from the original on 7 October 2022. Retrieved 20 September 2019.
In addition to spironolactone, which is a derivative of progesterone [...]
- ↑ Rey FO, Valterio C, Locatelli L, Ramelet AA, Felber JP (April 1988). "Lack of endocrine systemic side effects after topical application of spironolactone in man". Journal of Endocrinological Investigation. 11 (4): 273–8. doi:10.1007/BF03350151. PMID 3411088. S2CID 30535049.
- ↑ Rifka SM, Pita JC, Vigersky RA, Wilson YA, Loriaux DL (February 1978). "Interaction of digitalis and spironolactone with human sex steroid receptors". The Journal of Clinical Endocrinology and Metabolism. 46 (2): 338–44. doi:10.1210/jcem-46-2-338. PMID 86546.
- ↑ Pugeat MM, Dunn JF, Nisula BC (July 1981). "Transport of steroid hormones: interaction of 70 drugs with testosterone-binding globulin and corticosteroid-binding globulin in human plasma". The Journal of Clinical Endocrinology and Metabolism. 53 (1): 69–75. doi:10.1210/jcem-53-1-69. PMID 7195405.
- ↑ Kaulhausen H, Rohner HG, Siedek M, Lafosse M, Breuer H (February 1980). "[Binding capacity of sex hormone binding globulin and corticosteroid binding globulin in serum of male patients with liver cirrhosis (author's transl)]". Journal of Clinical Chemistry and Clinical Biochemistry. Zeitschrift für klinische Chemie und klinische Biochemie (in German). 18 (2): 137–43. PMID 7189544.
- ↑ Bland KI, Copeland III EM (9 September 2009). The Breast: Comprehensive Management of Benign and Malignant Diseases. Elsevier Health Sciences. pp. 161–. ISBN 978-1-4377-1121-9. Archived from the original on 7 October 2022. Retrieved 14 September 2017.
- ↑ Murck H, Büttner M, Kircher T, Konrad C (2014). "Genetic, molecular and clinical determinants for the involvement of aldosterone and its receptors in major depression". Nephron Physiology. 128 (1–2): 17–25. doi:10.1159/000368265. PMID 25376974. S2CID 19905165.
- ↑ Künzel HE (March 2012). "Psychopathological symptoms in patients with primary hyperaldosteronism--possible pathways". Hormone and Metabolic Research. 44 (3): 202–7. doi:10.1055/s-0032-1301921. PMID 22351473. S2CID 23273751.
- 1 2 Varin F, Tu TM, Benoît F, Villeneuve JP, Théorêt Y (February 1992). "High-performance liquid chromatographic determination of spironolactone and its metabolites in human biological fluids after solid-phase extraction". Journal of Chromatography. 574 (1): 57–64. doi:10.1016/0378-4347(92)80097-A. PMID 1629288.
- ↑ Oxford Textbook of Medicine: Vol. 1. Oxford University Press. 2003. pp. 1–. ISBN 978-0-19-262922-7. Archived from the original on 7 October 2022. Retrieved 6 October 2016.
- ↑ Anzenbacher P, Zanger UM (23 February 2012). Metabolism of Drugs and Other Xenobiotics. John Wiley & Sons. pp. 166, 169. ISBN 978-3-527-64632-6. Archived from the original on 7 October 2022. Retrieved 12 August 2018.
- ↑ Smith BT, Seaward BL, Smith BT (1 November 2014). Pharmacology for Nurses. Jones & Bartlett Publishers. pp. 169–. ISBN 978-1-4496-8940-7. Archived from the original on 7 October 2022. Retrieved 6 October 2016.
- ↑ Ortiz de Montellano PR (13 March 2015). Cytochrome P450: Structure, Mechanism, and Biochemistry. Springer. pp. 867–. ISBN 978-3-319-12108-6. Archived from the original on 7 October 2022. Retrieved 12 August 2018.
CYP3A4 catalyzes 6β-hydroxylation of progesterone, cortisol, and testosterone; this reaction accounts for a considerable amount of hormone inactivation, particularly when it is orally administered.
- ↑ Advances in Clinical Chemistry. Academic Press. 31 December 2012. pp. 69–. ISBN 978-0-12-405852-1.
- ↑ Brittain HG (26 November 2002). Analytical Profiles of Drug Substances and Excipients. Academic Press. p. 309. ISBN 978-0-12-260829-2. Archived from the original on 21 June 2013. Retrieved 27 May 2012.
- 1 2 Jameson JL, De Groot LJ (18 May 2010). Endocrinology - E-Book: Adult and Pediatric. Elsevier Health Sciences. pp. 2401–. ISBN 978-1-4557-1126-0.
[Spironolactone] is a potent antimineralocorticoid which was developed as a progestational analog [...]
- 1 2 3 4 Elks J (14 November 2014). The Dictionary of Drugs: Chemical Data: Chemical Data, Structures and Bibliographies. Springer. p. 1111. ISBN 978-1-4757-2085-3. Archived from the original on 15 February 2017.
- 1 2 "Spironolactone". Archived from the original on 30 June 2016. Retrieved 4 July 2017.
- 1 2 "Spironolactone | C24H32O4S". ChemSpider. Royal Society of Chemistry. Archived from the original on 9 September 2017. Retrieved 4 July 2017.
- ↑ Simon JA (December 1995). "Micronized progesterone: vaginal and oral uses". Clinical Obstetrics and Gynecology. 38 (4): 902–14. doi:10.1097/00003081-199538040-00024. PMID 8616985.
- ↑ Hu X, Li S, McMahon EG, Lala DS, Rudolph AE (August 2005). "Molecular mechanisms of mineralocorticoid receptor antagonism by eplerenone". Mini Reviews in Medicinal Chemistry. 5 (8): 709–18. doi:10.2174/1389557054553811. PMID 16101407.
- 1 2 Kuhl H (August 2005). "Pharmacology of estrogens and progestogens: influence of different routes of administration". Climacteric. 8 (Suppl 1): 3–63. doi:10.1080/13697130500148875. PMID 16112947. S2CID 24616324.
- ↑ Cutler GB, Pita JC, Rifka SM, Menard RH, Sauer MA, Loriaux DL (July 1978). "SC 25152: A potent mineralocorticoid antagonist with reduced affinity for the 5 alpha-dihydrotestosterone receptor of human and rat prostate". The Journal of Clinical Endocrinology and Metabolism. 47 (1): 171–5. doi:10.1210/jcem-47-1-171. PMID 263288.
- ↑ Hertz R, Tullner WW (November 1958). "Progestational activity of certain steroid-17-spirolactones". Proceedings of the Society for Experimental Biology and Medicine. 99 (2): 451–2. doi:10.3181/00379727-99-24380. PMID 13601900. S2CID 20150966.
- ↑ The British Encyclopaedia of Medical Practice: Medical progress. Butterworth & Company. 1961. p. 302. Archived from the original on 7 October 2022. Retrieved 2 February 2018.
Cena and Kagawa first synthesized 3-(3-oxo-17β-hydroxy-4-androsten-17α-yl)-propionic acid-gamma-lactone and later prepared its 19-nor analogue. These compounds were designated SC-5233 and SC-8109, respectively. Both have anti-aldosterone activity and most of the early work on aldosterone antagonism was done with their aid. SC-5233 is not appreciably absorbed when given by mouth and the parenteral dose is large.
- ↑ Larik FA, Saeed A, Shahzad D, Faisal M, El-Seedi H, Mehfooz H, Channar PA (February 2017). "Synthetic approaches towards the multi target drug spironolactone and its potent analogues/derivatives". Steroids. 118: 76–92. doi:10.1016/j.steroids.2016.12.010. PMID 28041953. S2CID 7003499.
- 1 2 Kagawa CM, Cella JA, Van Arman CG (November 1957). "Action of new steroids in blocking effects of aldosterone and desoxycorticosterone on salt". Science. 126 (3281): 1015–6. Bibcode:1957Sci...126.1015K. doi:10.1126/science.126.3281.1015. PMID 13486053.
- 1 2 Liddle GW (November 1957). "Sodium diuresis induced by steroidal antagonists of aldosterone". Science. 126 (3281): 1016–8. Bibcode:1957Sci...126.1016L. doi:10.1126/science.126.3281.1016. PMID 13486054.
- ↑ Engel J, Kleemann A, Kutscher B, Reichert D (14 May 2014). Pharmaceutical Substances, 5th Edition, 2009: Syntheses, Patents and Applications of the most relevant APIs. Thieme. pp. 1279–1280. ISBN 978-3-13-179275-4. Archived from the original on 7 October 2022. Retrieved 27 December 2016.
- ↑ Landau R, Achilladelis B, Scriabine A (1999). Pharmaceutical Innovation: Revolutionizing Human Health. Chemical Heritage Foundation. pp. 198–. ISBN 978-0-941901-21-5. Archived from the original on 7 October 2022. Retrieved 27 December 2016.
Spironolactone was patented in 1961 and has been used since then to treat heart failure, liver cirrhosis, and nephrotic syndrome.
- ↑ Jugdutt BI (19 February 2014). Aging and Heart Failure: Mechanisms and Management. Springer Science & Business Media. pp. 175–. ISBN 978-1-4939-0268-2. Archived from the original on 7 October 2022. Retrieved 27 December 2016.
- ↑ Wermuth CG (2 May 2011). The Practice of Medicinal Chemistry. Academic Press. pp. 34–. ISBN 978-0-08-056877-5. Archived from the original on 21 June 2013.
- ↑ Smith WG (1962). "Spironolactone and gynaecomastia". The Lancet. 280 (7261): 886. doi:10.1016/S0140-6736(62)90668-2. ISSN 0140-6736.
- ↑ Steelman SL, Brooks JR, Morgan ER, Patanelli DJ (October 1969). "Anti-androgenic activity of spironolactone". Steroids. 14 (4): 449–50. doi:10.1016/s0039-128x(69)80007-3. PMID 5344274.
- ↑ Stewart ME, Pochi PE (April 1978). "Antiandrogens and the skin". International Journal of Dermatology. 17 (3): 167–79. doi:10.1111/j.1365-4362.1978.tb06057.x. PMID 148431. S2CID 43649686.
- ↑ Neill JD, Johansson ED, Datta JK, Knobil, E (1968). "Endocrinology: Relationship Between the Plasma Levels of Luteinizing Hormone and Progesterone During the Normal Menstrual Cycle". Obstetrical & Gynecological Survey. 23 (3): 271–277. doi:10.1097/00006254-196803000-00006.
17a-methyl-B-nortestosterone (Benorterone) (SKF-7690) has satisfactorily undergone extensive pharmacologic and toxicologic studies in animals, plus preliminary clinical studies in humans with somewhat encouraging results. It was therefore subjected to further clinical trials, especially in relation to the treatment of acne vulgaris. This communication reports the promptly reversible development of gynecomastia in 12 of 13 postpuberal males who participated in such a clinical study. It is believed that this complication has not been reported previously with a nonestrogenic antiandrogenic agent.
- ↑ Tindall DJ, Chang CH, Lobl TJ, Cunningham GR (1984). "Androgen antagonists in androgen target tissues". Pharmacology & Therapeutics. 24 (3): 367–400. doi:10.1016/0163-7258(84)90010-X. PMID 6205409.
- ↑ Ober KP, Hennessy JF (November 1978). "Spironolactone therapy for hirsutism in a hyperandrogenic woman". Annals of Internal Medicine. 89 (5 Pt 1): 643–4. doi:10.7326/0003-4819-89-5-643. PMID 717935.
- ↑ Boisselle A, Tremblay RR (September 1979). "New therapeutic approach to the hirsute patient". Fertility and Sterility. 32 (3): 276–9. doi:10.1016/s0015-0282(16)44232-9. PMID 488407.
- ↑ Shapiro G, Evron S (September 1980). "A novel use of spironolactone: treatment of hirsutism". The Journal of Clinical Endocrinology and Metabolism. 51 (3): 429–32. doi:10.1210/jcem-51-3-429. PMID 7410528.
- ↑ Curtis M (2014). Glass' Office Gynecology. Lippincott Williams & Wilkins. pp. 47–. ISBN 978-1-60831-820-9.
- ↑ Shah D, Bhathena RK, Shroff S (2004). The Polycystic Ovary Syndrome. Orient Blackswan. pp. 78–. ISBN 978-81-250-2633-4. Archived from the original on 7 October 2022. Retrieved 4 July 2017.
- ↑ Hillard PJ (29 March 2013). Practical Pediatric and Adolescent Gynecology. John Wiley & Sons. pp. 371–. ISBN 978-1-118-53857-9. Archived from the original on 7 October 2022. Retrieved 4 July 2017.
- ↑ Dahl M, Feldman JL, Goldberg JM, Jaberi A (2006). "Physical Aspects of Transgender Endocrine Therapy". International Journal of Transgenderism. 9 (3–4): 111–134. doi:10.1300/J485v09n03_06. ISSN 1553-2739. S2CID 146232471.
- ↑ Prior JC, Vigna YM, Watson D, Diewold P, Robinow O. "Spironolactone in the presurgical therapy of male to female transsexuals: Philosophy and experience of the Vancouver Gender Dysphoria Clinic". Journal of Sex Information & Education Council of Canada (1): 1–7.
- ↑ Fisher AD, Maggi M (2015). "Endocrine Treatment of Transsexual Male-to-Female Persons". Management of Gender Dysphoria. pp. 83–91. doi:10.1007/978-88-470-5696-1_10. ISBN 978-88-470-5695-4.
- 1 2 Dorfman RI (5 December 2016). Steroidal Activity in Experimental Animals and Man. Elsevier Science. pp. 392–. ISBN 978-1-4832-7299-3.
- ↑ Gláz E, Vecsei P (11 January 2017). Aldosterone: International Series of Monographs in Pure and Applied Biology. Elsevier Science. p. 379. ISBN 978-1-4831-5997-3. Archived from the original on 10 October 2022. Retrieved 31 December 2020.
- 1 2 Morton IK, Hall JM (31 October 1999). Concise Dictionary of Pharmacological Agents: Properties and Synonyms. Springer Science & Business Media. pp. 261–. ISBN 978-0-7514-0499-9. Archived from the original on 7 October 2022. Retrieved 1 December 2016.
- ↑ Jjemba PK (3 October 2008). Pharma-Ecology: The Occurrence and Fate of Pharmaceuticals and Personal Care Products in the Environment. John Wiley & Sons. pp. 62–. ISBN 978-0-470-37024-7. Archived from the original on 7 October 2022. Retrieved 2 January 2019.
- 1 2 "The Top 300 of 2019". clincalc.com. Archived from the original on 18 March 2020. Retrieved 22 December 2018.
- 1 2 3 4 Benign Prostatic Hypertrophy. Springer Science & Business Media. 6 December 2012. pp. 266–. ISBN 978-1-4612-5476-8. Archived from the original on 7 October 2022. Retrieved 30 July 2017.
- 1 2 3 4 5 6 Matzkin H, Braf Z (January 1991). "Endocrine treatment of benign prostatic hypertrophy: current concepts". Urology. 37 (1): 1–16. doi:10.1016/0090-4295(91)80069-j. PMID 1702565.
- 1 2 Castro JE, Griffiths HJ, Edwards DE (July 1971). "A double-blind, controlled, clinical trial of spironolactone for benign prostatic hypertrophy". The British Journal of Surgery. 58 (7): 485–9. doi:10.1002/bjs.1800580703. PMID 4104441. S2CID 27601630.
- ↑ Scott WW, Menon M, Walsh PC (April 1980). "Hormonal Therapy of Prostatic Cancer". Cancer. 45 (Suppl 7): 1929–1936. doi:10.1002/cncr.1980.45.s7.1929. PMID 29603164. S2CID 4492779.
- ↑ Smith JA (January 1987). "New methods of endocrine management of prostatic cancer". The Journal of Urology. 137 (1): 1–10. doi:10.1016/S0022-5347(17)43855-9. PMID 3540320.
- 1 2 3 Verma D, Thompson J, Swaminathan S (March 2016). "Spironolactone blocks Epstein-Barr virus production by inhibiting EBV SM protein function". Proceedings of the National Academy of Sciences of the United States of America. 113 (13): 3609–14. Bibcode:2016PNAS..113.3609V. doi:10.1073/pnas.1523686113. PMC 4822607. PMID 26976570.
- ↑ Pelle MT, Crawford GH, James WD (October 2004). "Rosacea: II. Therapy". Journal of the American Academy of Dermatology. 51 (4): 499–512, quiz 513–4. doi:10.1016/j.jaad.2004.03.033. PMID 15389184.
- ↑ Merticariu A, Marinescu L, Giurcăneanu C (2016). "Rosacea and its comorbidities". Journal of Translational Medicine and Research. 21 (1): 17. doi:10.21614/jtmr-21-1-68. ISSN 2393-4999.
- ↑ Wollina U (2014). "Nonclassical Treatments". Pathogenesis and Treatment of Acne and Rosacea. pp. 713–717. doi:10.1007/978-3-540-69375-8_95. ISBN 978-3-540-69374-1.
- ↑ Spoendlin J, Voegel JJ, Jick SS, Meier CR (October 2013). "Spironolactone may reduce the risk of incident rosacea". The Journal of Investigative Dermatology. 133 (10): 2480–2483. doi:10.1038/jid.2013.186. PMID 23594595.
- ↑ Wernze H, Herdegen T (April 2014). "Long-term efficacy of spironolactone on pain, mood, and quality of life in women with fibromyalgia: An observational case series". Scandinavian Journal of Pain. 5 (2): 63–71. doi:10.1016/j.sjpain.2013.12.003. PMID 29913681. S2CID 49305801.
- ↑ Kalso E (April 2014). "From patient observation to potential new therapies-Is old spironolactone a new analgesic?". Scandinavian Journal of Pain. 5 (2): 61–62. doi:10.1016/j.sjpain.2014.02.006. PMID 29913669. S2CID 49298333.
- ↑ McElroy SL, Guerdjikova AI, Mori N, O'Melia AM (October 2012). "Current pharmacotherapy options for bulimia nervosa and binge eating disorder". Expert Opinion on Pharmacotherapy. 13 (14): 2015–26. doi:10.1517/14656566.2012.721781. PMID 22946772. S2CID 1747393.
